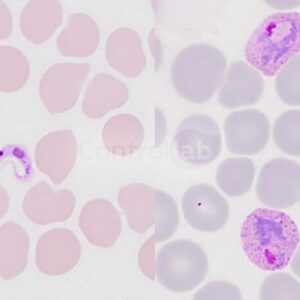

Program Center




- CLProgramAbnormal Urinalysis and Sedimentoscopy (AUS)CategoryClinical, Internal Control, Proficiency Testing, Urinelysis
Abnormal Urinalysis (AU)
- Bilirrubin
- Ketone bodies
- Strip Reading Density
- Density by direct sample reading
- Glucose
- Hemoglobin
- Leukocytes
- Nitrite
- PH in Strip Reading
- Proteins
- Urobilinogen
Sedimentoscopy urinalysis 1
- Red Cells
- Leukocytes
- Identification
Related test
¹Urinary sediment analysis
- CLProgramAbuse Drugs – Urine by AutomatizationCategoryClinical, Occupational Toxicology / Abuse Drugs, Proficiency Testing
- 6-acetylcodeine
- 6-acetylmorphine
- Alprazolan
- Amobarbital
- Amphetamine
- Benzoylecgonine
- Bromazepan
- Butalbital
- Clonazepam
- Cocaethylene
- Cocaine
- Codeine
- Codeine Glucuronide
- Crack (AEME)
- Diclofenac
- Dihydrocodeine
- Dizepam
- Ecstasy (MDMA)
- EDDP
- Ephedrine
- Fenproporex
- Fentanyl
- Flunitrazepam
- Fluoxetine
- Flurazepam
- Heroin
- Ketamine
- Lorazepam
- Lormetazepam
- LSD
- Marijuana (carboxylic THC) Glucuronide
- Marijuana (THC)
- Mazindol
- MDA
- MDEA
- Meperedine
- Mephedrone
- Methadone
- Methamphetamine
- Methaqualone
- Midazolam
- Morphine
- Morphine Glucuronide
- Nitrazepam
- Norcocaine
- Nordiazepam
- Norketamine
- Norpropoxyphene
- Nortriptyline
- Oxazepam
- Oxycodone
- Pentobarbital
- Phenacetin
- Phencyclidine (PCP)
- Phenobarbital
- Propoxyphene
- Secobarbital
- Temazepam
- Tramadol
- Zolpidem
- Zopiclone
- CLProgramAcinetobacter baumannii – Molecular BiologyCategoryClinical, Genetics and Molecular Biology, Proficiency Testing
The program includes PCR-based molecular testing.
The samples contain the complete genome of the microorganism.- Detection of Acinetobacter baumannii
- VETProgramAdenovirus – Molecular BiologyCategoryGenetics and Molecular Biology, Internal Control, Proficiency Testing, Veterinary
The program includes PCR-based molecular testing.
The samples contain the complete genome of the microorganism.Adenovirus.
- CLProgramAdenovirus – Molecular BiologyCategoryClinical, Genetics and Molecular Biology, Internal Control, Proficiency Testing
The program includes PCR-based molecular testing.
The samples contain the complete genome of the microorganism.- Adenovirus.
- CLProgramAdenovirus: AntigenCategoryClinical, Clinical Microbiology, Internal Control, Proficiency Testing
Adenovirus: Antigen
- VETProgramAdenovirus: Antigen ScreeningCategoryClinical Microbiology, Internal Control, Proficiency Testing, Veterinary
Adenovirus: Antigen Screening
Blood Culture for Aerobes
- Culture
- Identification
- Bacterioscopy Gram
- Antimicrobial Susceptibility Test
- CLProgramAFB BacilloscopyCategoryClinical, Clinical Microbiology, Internal Control, Proficiency Testing
AFB Bacilloscopy¹
¹Related Tests
AFB Bacilloscopy
AFB – Direct Bacilloscopy Research
- PCProgramAlcoholic Distilled – BeveragesCategoryFood, Physicochemical, Proficiency Testing, Releases
Alcoholic Distilled – Beverages
- Methanol
- Methanol
• Alcoholic Drinks – Wine
Alcohol Degree at 20 ºC
Chlorides
Density
Free SO2
pH
Sulfates
Total Acidity
Total SO2
Allergy I
- D1 – D. pteronyssinus
- D2 – D. farinae
- D201 – B. tropicalis
- D3 – Dermatophagoides microceras
- D70 – Acarus siro
- D71 – Lepidoglyphus destructor
- D72 – T. putrescentiae
- D73 – G. domesticus
- D74 – Eurogliphus maynei
- HX2 – Household dust
- IgE Total
Allergy II
- FX2 – Seafood
- F3 – Fish (cod)
- F23 – Crab/Siri
- F24 – Shrimp
- F37 – Blue Mussel
- F40 – Tuna
- F41 – Salmon
Allergy III
- Ex1 – Animal Epithelium
- E1 – Cat Dander
- E2 – Dog Epithelium
- E3 – Horse Dander
- E5 – Dog Dander
Allergy IV
- Mx1 – Fungi and Yeasts
- M1 – Penicillium chrysogenum
- M2 – Cladosporium herbarum
- M3 – Aspergillus fumigatus
- M5 – Candida albicans
- M6 – Alternaria alternata
Allergy V
- F1 – Egg White
- F2 – Milk
- F4 – Wheat
- F14 – Soy
- F75 – Egg Yolk
- F76 – Alfa lactoalbumina
- F77 – Beta lactoglobulina
- F78 – Casein
Allergy VI
- I1 – Bee
- I3 – Common Wasp
- l4 – Wasp
- I6 – German Cockroach (Blattella germanica)
- I70 – Ant
- I71 – Common mosquito
- I206 – American Cockroach (Periplaneta americana)
Allergy VI
- I1 – Bee
- I3 – Common Wasp
- l4 – Wasp
- I6 – Cockroach (Blattella germanica)
- I206 – Cockroach (Periplaneta americana)
- I70 – Ant
- I71 – Common mosquito
Allergy VII
- FX1 – Food
- F13 – Peanut
- F17 – Hazelnut
- F18 – Brazilian Nut
- F20 – Almond
- F36 – Coconut
- F299 – Portuguese Nut
Allergy VIII
- FX9 – Food
- F84 – Kiwi
- F87 – Melon
- F92 – Banana
- F259 – Grape
- CLProgramAmbulatory and Hospital BacteriologyCategoryClinical, Clinical Microbiology, Internal Control, Proficiency Testing
Ambulatory Bacteriology
- Culture
- Identification (culture) of microorganisms in the ambulatory environment
- Antimicrobial Susceptibility Test
Hospital Bacteriology
- Culture
- Identification (culture) of microorganisms in the hospital environment
- Antimicrobial Susceptibility Test
- Aspartic Acid
- Glutamic Acid
- Alanine
- Arginine
- Asparagine
- Citrulline
- Phenylalanine
- Glycine
- Glutamine
- Hydroxyproline
- Histidine
- Isoleucine
- Leucine
- Lysine
- Methionine
- Ornithine
- Proline
- Serine
- Taurine
- Tyrosine
- Threonine
- Tryptophan
- Valine
- Aspartic Acid
- Glutamic Acid
- Alanine
- Arginine
- Asparagine
- Citrulline
- Phenylalanine
- Glycine
- Glutamine
- Hydroxyproline
- Histidine
- Isoleucine
- Leucine
- Lysine
- Methionine
- Ornithine
- Proline
- Serine
- Taurine
- Tyrosine
- Threonine
- Tryptophan
- Valine
- Cytoplasmic
- Mitotic apparatus
- Mixed
- Nuclear
- Nucleolar
Related Tests
Anti-nuclear factor
- Anaerobic Research
- Gram Bacterioscopy
- Culture
- Antimicrobial Susceptibility Testing (AST)
- Bacterioscopy Gram
- Culture
- Identification
- CLProgramAnemiaCategoryClinical, Immunoassays / Endocrinology, Internal Control, Proficiency Testing
Anemia I
-
Hepcidin
-
Iron
-
Receptor de Transferrina Sérica (Serum Transferrin Receptor)
-
Total Iron Binding Capacity (TIBC)
-
Transferrin
-
Transferrin Saturation
-
Unbound Iron Binding Capacity (UIBC)
Anemia II
-
Ferritin
-
Folic Acid (Folate)
-
Holotranscobalamin
-
Methylmalonic Acid (MMA)
-
Prealbumin
-
TSH
-
Vitamin B12
-
- CLProgramAnti-CCP – ImmunologyCategoryClinical, Immunology / Proteins, Internal Control, Proficiency Testing
Anti-CCP – Immunology
- CLProgramAnti-HAV – ImmunologyCategoryClinical, Immunology / Proteins, Internal Control, Proficiency Testing
- Anti-HAV IgG
- Anti-HAV IgM
- Total Anti-HAV
Related Test
- Hepatitis A
- Anti-HBc IgG
- Anti-HBc IgM
- Total Anti-HBc
Related test
- Hepatitis B Antibodies against the hepatitis B virus core.
- CLProgramAnti-thyroid peroxidase (anti-TPO) – ImmunologyCategoryClinical, Immunology / Proteins, Internal Control, Proficiency Testing
Anti-thyroid peroxidase (anti-TPO) – Immunology
- CLProgramAnti-Xa ActivityCategoryClinical, Coagulation / Haemostasis, Internal Control, Proficiency Testing
Anti-Xa Activity
- CLProgramAnticardiolipin – ImmunologyCategoryClinical, Immunology / Proteins, Internal Control, Proficiency Testing
- Anticardiolipin IgA
- Anticardiolipin IgG
- Anticardiolipin IgM
- CLProgramAntiphospholipid Antibodies – ImmunologyCategoryClinical, Immunology / Proteins, Proficiency Testing
- Beta-2-glycoprotein IgA
- Beta-2-glycoprotein IgG
- Beta-2-glycoprotein IgM
- Phosphatidylserine IgA
- Phosphatidylserine IgG
- Phosphatidylserine IgM
- Aspirin Reaction Units (ARU)
- P2Y12 Reaction Units (PRU)
- CLProgramAntistreptolysin O – immunologyCategoryClinical, Immunology / Proteins, Internal Control, Proficiency Testing
Antistreptolysin O¹ – Immunology
Related tests
¹ASO
¹ASLO
¹AEO - CLProgramApolipoprotein E – Molecular BiologyCategoryClinical, Genetics and Molecular Biology, Proficiency Testing
The program includes PCR-based molecular testing.
- Genotypes Apolipoprotein E
- Aspergillus spp. Total
- Aspergillus fumigatus IgA
- Aspergillus fumigatus IgG
- Aspergillus fumigatus IgM
- Aspergillus fumigatus Total
- CLProgramAspergillus spp. – Molecular BiologyCategoryClinical, Genetics and Molecular Biology, Proficiency Testing
The program includes PCR-based molecular testing.
The samples contain the complete genome of the microorganism.- Aspergillus spp.
Autoimmunity I
- Anti-DNA
- Anti-ENA
- Anti-RNP
- Anti-RNP/Sm
- Anti-Sm
- Anti-SS-A (Ro)
- Anti-SS-A/SS-B
- Anti-SS-B (La)
Autoimmunity II
- Anti-centromere
- Anti-Jo1
- Anti-Scl70
Autoimmunity III
- ANCA
- Anti-LKM1
- Anti-Mitochondria
- Anti-MPO
- Anti-PR3
- Anti-Smooth Muscle
Autoimmunity IV
- Anti-Endomysium IgA
- Anti-Endomysium IgG
- Anti-gliadin IgA
- Anti-gliadin IgG
- Anti-Tissue Transglutaminase (tTG) IgA
- Anti-Tissue Transglutaminase (tTG) IgG
Autoimmunity V
- ASCA IgA
- ASCA IgG
Autoimmunity VI
- Anti-Reticulin IgA
- Anti-Reticulin IgG
- Anti-Reticulin IgM
- Anti-ReticulinTotal
Circulating Immunocomplexes
- CLProgramAutomated Sperm Cell CountCategoryClinical, Internal Control, Proficiency Testing, Reproduction Medicine
Automated Sperm Cell Count
Bacteriology
- Culture, identification and sensitivity testing
- CLProgramBartonella henselae – ImmunologyCategoryClinical, Immunology / Proteins, Proficiency Testing
- Bartonella henselae IgG
- Bartonella henselae IgM
- 17-Ketosteroids (17-KS)
- 17-Hydroxycorticosteroids (17-OH)
- 3-Methoxytyramine (3-MT)
- 5-Hydroxy Indoleacetic Acid (HIAA)
- Aspartic Acid
- Gamma Aminobutyric Acid (GABA)
- Glutamic Acid
- Homovanillic Acid (HVA)
- Methylmalonic Acid
- Orotic Acid
- Vanillylmandelic Acid (VMA)
- Alanine
- Aldosterone
- Cyclic AMP
- Arginine
- Asparagine
- Beta-2-microglobulin
- Cotinine
- Dopamine
- Epinephrine (Adrenaline)
- Iron
- Total Hydroxyproline
- Histamine
- Homocysteine
- IgA
- IgG
- Iodine
- Metanephrine
- Myoglobin
- Nicotine
- Norepinephrine (Noradrenaline)
- Normetanephrine
- Homogentisic acid screening
- Homocystine screening
- Myoglobin screening
- Mucopolysaccharide screening
- Retinol Binding Protein
- Serotonin
- Transferrin
Biochemistry I
- Albumin
- Adjusted Calcium
- Alkaline Phosphatase (ALP)
- Angiotensin-converting enzyme (ACE)
- CPK/CK (Creatinokinase)
- Creatinine
- Direct Bilirubin
- D-3-hydroxybutyrate
- Ferro
- gGT (Glutamyl Transferase Range)
- Glucose
- Glomerular Filtration Rate
- HDL cholesterol
- Indirect Bilirubin
- LDH (Total Lactic Dehydrogenase)
- LDH 1 (Dosage)
- Magnesium
- Phosphor
- Potassium
- PSA Total
- Sodium
- TGO/AST
- TGP/ALT
- Total Amylase
- Total Bile Acids
- Total Bilirubin
- Total Calcium
- Total cholesterol
- Total Proteins
- Triglycerides
- Urea
- Urea Nitrogen (BUN)
- Uric Acid
- VLDL cholesterol
Biochemistry II
- 5’Nucleotidase
- Aldolase
- Alpha Galactosidase
- Alpha Hydroxybutyrate Dehydrogenase (HBDH)
- Alpha-N-acetylglycosaminidase
- Biotinidase
- Chlorides
- Cholinesterase with Dibucaine Inhibition
- Citrate (Citric Acid)
- CK-MB Activity
- CK-MB Mass
- Cortisol
- Free Fatty Acids (NEFA)
- Free T3
- Free T4
- Frutosamine
- GLDH (Glutamate Dehydrogenage)
- Ionic Calcium
- Lactic Acid (Lactate)
- LDL cholesterol
- Leucinaminopeptidase (LAP)
- Lipase
- Lithium
- Non-Prostatic Acid Phosphatase
- Osmolality
- Pancreatic Amylase
- Phyanic Acid
- Plasma Cholinesterase
- Pristanic Acid
- Prostatic Acid Phosphatase (PAP)
- Salivary Amylase
- T3 Funding
- T3 Reverse
- T3 Total
- T4 Total
- Total Acid Phosphatase
- Total Iron Binding Capacity
Biochemistry III
- Baking soda
- Carbon Dioxide (CO2) Total
- D-xilose
Biochemistry IV
- Vitamin B1 (Thiamine)
- Vitamin B1 (Thiamine Monophosphate – TMP)
- Vitamin B1 (Total Thiamine)
- Vitamin B2 (Riboflavin)
- Vitamin B6 (Pyridoxine 5’phosphate – PLP)
Bioquímica V
- Vitamin B1 (Total Thiamine)
- Vitamin B1 (Thiamine Pyrophosphate – TPP)
- Vitamin B2 (Riboflavin)
- Vitamin B2 (Total Riboflavin)
- Vitamin B2 (Flavin Adenine Dinucleotide – FAD)
- Vitamin B2 (Flavin Mononucleotide)
- Vitamin B3 (Niacin)
- Vitamin B5 (Pantothenic Acid)
- Vitamin B6 (Pyridoxal 5’Phosphate – PLP)
- Vitamin B7 (Biotin)
Biochemistry VI
- Macroamilase
- Total Amylase
Biochemistry VII
- Mucoproteins (in Tyrosine)
Biochemistry I
- Albumin
- Alkaline Phosphatase
- Amylase
- CK-MB Activity
- CK-MB Mass
- CPK
- Creatinine
- Direct Bilirubin
- Fructosamine
- gGT
- Glucose
- HDL Cholesterol
- Ionic Calcium
- Iron
- Ketone (Ketonemia)
- LDL Cholesterol
- Lipase
- Osmolality
- Phosphor
- Potassium
- Sodium
- TGO/AST
- TGP/ALT
- Total Bilirubin
- Total Calcium
- Total Cholesterol
- Total Lipids
- Total Proteins
- Triglycerides
- Urea
- VLDL Cholesterol
Biochemistry II
- 1.25 (OH)2 Vitamin D
- 25 (OH) Vitamin D
- ADA
- Aldolase
- Ammonia
- Angiotensin Converting Enzyme
- B12 Vitamin
- Beta Carotene
- Bile Acids
- Chap. Iron Fixation Free
- Chap. Total Iron Fixation
- Chlorides
- Cholinesterase
- Copper
- D-Xylose
- Folic Acid
- Lactic Acid
- LDH
- Leucine Aminopeptidase (LAP)
- Magnesium
- Prostatic Acid Phosphatase
- Total Acid Phosphatase
- Uric Acid
- Vitamin A8
- CLProgramBiochemistry – Amniotic FluidCategoryClinical, Maternal-Fetal Medicine, Proficiency Testing
- Albumin
- Alkaline phosphatase
- Amylase
- Beta-HCG
- Chlorides
- Creatinine
- gGT
- Glucose
- Ionic Calcium
- LDH
- Magnesium
- Osmolality
- pH
- Potassium
- progesterone
- Sodium
- Total Bilirubin
- Total Calcium
- Total Proteins
- Total Testosterone
- Urea
- Uric acid
- Zinc
- CLProgramBiochemistry of SpermCategoryClinical, Internal Control, Proficiency Testing, Reproduction Medicine
- Citric acid
- Fructose
- Zinc
- CLProgramBiochemistry V: Total BloodCategoryClinical, Clinical Chemistry, Internal Control, Proficiency Testing
Vitamin B1 (Thiamine)
Vitamin B2 (Riboflavin)
Vitamin B3 (Niacin)
Vitamin B5 (Pantothenic Acid)
Vitamin B6 (Pyridoxine)
Vitamin B7 (Biotin) Microbiological Analysis:
- Culture
- Identification
- Gram staining
Blood culture for Anaerobic
- Culture
- Identification
- Bacterioscopy Gram
- Antimicrobial Susceptibility Test
- Lactic Acid (Lactate)
- Bicarbonate (HCO3-)
- Base Buffer (BB)
- Ionic Calcium
- Chlorides
- Creatinine
- Carbon Dioxide (CO2)
- Base Excess (BE)
- Glucose
- Lithium
- Magnesium
- pH
- pCO2
- pO2
- Potassium
- Oxygen Saturation (SO2)
- Sodium
- Urea
- Lactic Acid (Lactate)
- Bicarbonate (HCO3-)
- Base Buffer (BB)
- Ionic Calcium
- Chlorides
- Creatinine
- Carbon Dioxide (CO2)
- Base Excess (BE)
- Glucose
- Lithium
- Magnesium
- pH
- pCO2
- pO2
- Potassium
- Oxygen Saturation (SO2)
- Sodium
- Urea
- CLProgramBone Marrow BiopsyCategoryClinical, Hematology / Hematoscopy, Internal Control, Proficiency Testing
Bone Marrow Biopsy
- CLProgramBordetella – Molecular BiologyCategoryClinical, Genetics and Molecular Biology, Internal Control, Proficiency Testing
The program includes PCR-based molecular testing.
The samples contain the complete genome of the microorganism.- Bordetella bronchiseptica
- Bordetella parapertussis
- Bordetella pertussis
- VETProgramBordetella – Molecular BiologyCategoryGenetics and Molecular Biology, Proficiency Testing, Veterinary
The program includes PCR-based molecular testing.
The samples contain the complete genome of the microorganism.- Bordetella bronchiseptica
Bordetella sp. – Culture
- CLProgramBorrelia burgdorferi – ImmunologyCategoryClinical, Immunology / Proteins, Proficiency Testing
- Borrelia burgdorferi IgG
- Borrelia burgdorferi IgM
- Total Borrelia burgdorferi
- Bovine Leukosis
Related tests
Enzootic Bovine Leukosis (EBL)
Brucellosis
Brucellosis
- CLProgramC-Reactive Protein – ImmunologyCategoryClinical, Immunology / Proteins, Internal Control, Proficiency Testing
- C-Reactive Protein – Immunology
Related tests
- Immunology – CRP
- Not ultrasensitive CRP
- CLProgramCalprotectinCategoryClinical, Coprology / Occult Blood, Internal Control, Proficiency Testing
Calprotectin
- CLProgramCampylobacter – Molecular BiologyCategoryClinical, Genetics and Molecular Biology, Proficiency Testing
The program includes PCR-based molecular testing.
The samples contain the complete genome of the microorganism.Detection by Molecular Biology of:
- Campylobacter coli.
- Campylobacter jeju.
- Campylobacter sp.
- VETProgramCampylobacter – Molecular BiologyCategoryGenetics and Molecular Biology, Proficiency Testing, Veterinary
The program includes PCR-based molecular testing.
The samples contain the complete genome of the microorganism.- Campylobacter coli.
- Campylobacter jejuni.
- Campylobacter spp.
- CLProgramCandida – Molecular BiologyCategoryClinical, Genetics and Molecular Biology, Proficiency Testing
The program includes PCR-based molecular testing.
The samples contain the complete genome of the microorganism.- Candida sp.
- Candida albicans
- Candida auris
- Candida glabrata
- Candida guilliermondii
- Candida krusei
- Candida parapsilosis
- Candida tropicalis
- VETProgramCanine Distemper – ImmunologyCategoryImmunology / Proteins, Internal Control, Proficiency Testing, Veterinary
- Canine Distemper IgG
- Canine Distemper IgM
- Canine Distemper Total
- VETProgramCanine Ehrlichiosis – ImmunologyCategoryImmunology / Proteins, Internal Control, Proficiency Testing, Veterinary
- Canine Ehrlichiosis IgG
- Canine Ehrlichiosis IgM
- Canine Ehrlichiosis Total
- VETProgramCanine HematologyCategoryHematology / Hematoscopy, Internal Control, Proficiency Testing, Veterinary
Tests included in Veterinary Hematology programs:
- Red blood cells
- Hemoglobin
- Hematocrit
- VCM
- HCM
- CHCM
- RDW
- Platelets
- VPM *
- PCT *
- PDW *
- Neutrophils *
- Lymphocytes *
- Monocytes *
- Eosinophils *
- Basophils *
- Granulocytes *
- MID *
- MXD *
- Leukocytes
* Tests offered as education.
** Legend I, II, III and IV correspond to Canine Hematology I, Canine Hematology II, Canine Hematology III and Canine Hematology IV.
Manufacturer Systems I II III IV Abbott Cell Dyn 1600/3200 Ruby/ 3500/ 3700 X Bayer Advia 120 X Beckman Coulter Coulter GEN-S/ Coulter Série AC.T/ Coulter T890/ Coulter JT X Bioclin Quibasa Hematoclin 2.8 Vet / Hematoclin 5.1 Vet X Bioeasy Bio 2900 X Bio Brasil VH20 X Biotécnica Hemabio III Vet X Boule Medical AB Exigo H400 X Brasmed HemoVet 2300 X Celm Celm CC 510/ 530 X Diamond Diagnostics MC-6200VET X Dymind DH 36/ 76/ DM 61 Vet/ DF 56 Vet X Diagno Icounter 3D/ Icounter Vet / Icounter VS X Equip VET3000 X Edan Foco X3 Vet/ H30 Vet/ H60 Vet X GT Group GT Count 3000/ GT Count 510 VET X Genius 6360 VET X GENRUI KT-6200 Vet X Horiba ABCvet X Horiba ABX Micros 45/CRP/ Micros 60/ Micros ESV 60/ Pentra 120 X Hemogam Hemacounter 60 X IDEXX LaserCyte Dx, ProCyte Dx X In Vitro Humacount 30TS/ 80TS/ Humacount Plus X Kovalent Mykov Cell 550/ Mykov Cell 550 Vet X Labtest Labtest AUD-H Vet/ Labtest SDH 20/ Labtest SDH 3 Vet X MedMax Max Cel 200/ 300/ 300Vet / 500D X Melet Melet Schloesing MS4 X Mindray BC-2800 / BC-2800 Vet / BC-30 Vet / BC-3200 / BC-5000 / BC-5000 Vet / BC-5500 / BC-780 / BC-700 X Nihon Kohden Celltac MEK-6500 / Celltac MEK-6550 / 9100 X Orphée Mythic 18 Vet X Procan Electronics PE 6800 X Quallyx Hemaray 51 VET X Radim HeCo Plus X Shenzhen Tecom TEK-VET3 / TEK-VET5 X Sysmex KX21N/ Poch 100i Vdiff/ XN-1000/ XP-300/ XS 800i/ XT 2000i 1800i X Siemens Advia 2120i X Urit BH-70P / BH-70Vet / URIT 3000 Plus / URIT 5160 / URIT 5160 Vet / URIT 5380 Vet X Wiener Counter 19 X Zybio EXC200 / Z51 Vet X - VETProgramCanine ImmunohematologyCategoryImmunohematology / Transfusion Medicine, Proficiency Testing, Veterinary
Canine Immunohematology
- Blood typing
- Crossmatch
- VETProgramCanine Parvovirosis – ImmunologyCategoryImmunology / Proteins, Internal Control, Proficiency Testing, Veterinary
- Canine Parvovirus IgG
- Canine Parvovirus IgM
- Canine Parvovirus Total
- CLProgramCardiac C-Reactive ProteinCategoryClinical, Immunology / Proteins, Internal Control, Proficiency Testing
Cardiac CRP¹
Related tests
¹Cardiac C-Reactive Protein
¹Ultrasensitive CRP
¹High Sensitivity CRP
¹hs CRP
Cardiac Markers I
- CK MB Mass
- Troponin T
Cardiac Markers II
- Creatine kinase (CK)
- CK MB Activity
Cardiac Markers III
- Galectin-3
- Homocysteine
- H-FABP
- LDH (Desidrogenase Láctica) Total
- Mioglobina
- Troponina I
Cardiac Markers BNP (Automation)
- BNP
Cardiac Markers NT-proBNP
- NT-proBNP
- VETProgramCardiac MarkersCategoryImmunology / Proteins, Internal Control, Proficiency Testing, Veterinary
- Troponin I
- VETProgramCardiac Markers: NT-proBNPCategoryCardiac Markers, Internal Control, Proficiency Testing, Veterinary
- NT-proBNP
- Dopamine
- Epinephrine (Adrenaline)
- Norepinephrine ((Noradrenaline))
- CLProgramCavity Fluids – MultiparametersCategoryBody Liquids, Clinical, Internal Control, Proficiency Testing
Cavity Fluids – Biochemistry
- Adenosine Deaminase (ADA)
- Albumin
- Alkaline Phosphatase (ALP)
- Amylase
- Chlorides
- Cholesterol
- Creatinine
- Density
- Ferritin
- Glucose
- GT range
- Lactic Acid (Lactate)
- Lactic Dehydrogenase (LDH)
- Lipase
- pH
- Potassium
- Sodium
- Total Bilirubin
- Total Calcium
- Total Proteins
- Triglycerides
- Urea
- Uric Acid
Cavity Fluids – Immunology
- Alpha-1-Acid Glycoprotein
- CA 125
- CA 15-3
- CA 19-9
- CEA
- C3 complement
- C4 complement
Cavity Fluids Count (Global)
- Nucleated Cells
- Red Cells
Cytology
- Atypical Cells (Suspected Neoplasia)
- Reactive Mesothelial Cells
- Typical Mesothelial Cells
- Reactive Lymphocytes
Cellular Identification
Identification (Camera)
- CLProgramCavity Fluids Cellular Count by AutomationCategoryBody Liquids, Clinical, Internal Control, Proficiency Testing
- Nucleated Cells
- Red Cells
- CD34+ Absolute and percentage
- CD45+ Absolute and Percentage
- CLProgramChagas – Molecular BiologyCategoryClinical, Genetics and Molecular Biology, Proficiency Testing
The program includes PCR-based molecular testing.
The samples contain the complete genome of the microorganism.- Detection of Trypanosoma cruzi
- CLProgramChikungunya – ImmunologyCategoryClinical, Infectious Diseases, Internal Control, Proficiency Testing
- Chikungunya IgG
- Chikungunya IgM
- CLProgramChikungunya – Molecular BiologyCategoryClinical, Genetics and Molecular Biology, Internal Control, Proficiency Testing
The program includes PCR-based molecular testing.
The samples contain the complete genome of the microorganism.- Chikungunya.
- CLProgramChlamydia – ImmunologyCategoryClinical, Infectious Diseases, Internal Control, Proficiency Testing
- Chlamydia IgG
- Chlamydia IgM
- Chlamydia IgA
- CLProgramChlamydia trachomatis – Molecular BiologyCategoryClinical, Genetics and Molecular Biology, Proficiency Testing
The program includes PCR-based molecular testing.
The samples contain the complete genome of the microorganism.- Detection of Chlamydia trachomatisby.
- CLProgramCitrobacter – Molecular BiologyCategoryClinical, Genetics and Molecular Biology, Proficiency Testing
The program includes PCR-based molecular testing.
The samples contain the complete genome of the microorganism.- Citrobacter sp.
- Citrobacter freundii
- Citrobacter koseri
- VETProgramClostridium – Molecular BiologyCategoryGenetics and Molecular Biology, Proficiency Testing, Veterinary
The program includes PCR-based molecular testing.
The samples contain the complete genome of the microorganism.- Clostridium sp.
- Clostridium botulinum
- Clostridium chauvoei
- Clostridium difficile
- Clostridium haemolyticum
- Clostridium novyi
- Clostridium perfringens
- Clostridium septicum
- Clostridium sordellii
- Clostridium tetani
- CLProgramClostridium difficile – AntigenCategoryClinical, Clinical Microbiology, Internal Control, Proficiency Testing
Clostridium difficile – Antigen
- CLProgramClostridium difficile – Molecular BiologyCategoryClinical, Genetics and Molecular Biology, Proficiency Testing
The program includes PCR-based molecular testing.
The samples contain the complete genome of the microorganism.- Clostridium difficile.
- CLProgramClostridium difficile – Toxin A and BCategoryClinical, Infectious Diseases, Internal Control, Proficiency Testing
Clostridium difficile – Toxin A and B
- VETProgramCoagulationCategoryCoagulation / Haemostasis, Internal Control, Proficiency Testing, Veterinary
- Fibrinogen
- TTPa – Time
- TTPa – Standard/Sample Ratio
- TAP – Time
- TAP – Activity
- TAP – INR
- CLProgramCoagulation and HemostasisCategoryClinical, Coagulation / Haemostasis, Internal Control, Proficiency Testing
Coagulation
- ACT (activated clotting time)
- Activated Partial Thromboplastin Time (APTT) – Time
- Functional Fibrinogen
- Immune Fibrinogen
- Prothrombin Time (PT) – Activity
- Prothrombin Time (PT) – INR
- Prothrombin Time (PT) – Time
- Sample/Standard Ratio (factor III Partial Thromboplastin Time)
Coagulation II (Hemostasis I)
- Antiplasmin
- Antithrombin III
- Factor II
- Factor IX
- Factor V
- Factor VII
- Factor VIII
- Factor X
- Factor XI
- factor XII
- Factor XIII
- Free S Protein
- Functional Protein C
- Functional S Protein
- Plasminogen
- Pre-Kallikrein
- Thrombin Time (TT)
Coagulation III (Hemostasis II)
- Activated Protein C (Endurance)
- Anti-prothrombin IgM
- Factor XIII (Qualitative for severe disability)
- Heparin Cofactor II (Activity)
- IgG anti-prothrombin
- Protein C (Antigen)
- Reptilase time
- Ristocetin Cofactor Activity
- Total S Protein
- Vitamin K
- Von Willebrand factor (antigenic)
- Von Willebrand Factor (Multimers)
Coagulation V
- Factor IX inhibitor
- Factor VII inhibitor
- Factor VIII inhibitor
- Tissue Plasminogen Inhibitor
Coenzyme Q10
Cafés, tés y productos de infusión
Recuento de bacterias:
- Bacterias mesófilas aerobias viables
- Escherichia coli
Prueba para:
- Salmonella spp.
The proficiency test is divided into 2 different programs according to the range analyzed in the laboratory routine:
• Conductivity I
Conductivity I (25ºC)• Conductivity II
Conductivity II (25ºC)- Identification (culture) of microorganisms
- Antimicrobial susceptibility testing
Microorganisms covered
- Enteroadherent E. coli
- Enterohaemorrhagic E. coli
- Enteroinvasive E. coli
- Enteropathogenic E. coli
- Enterotoxigenic E. coli
- Salmonella non typhi
- Salmonella sp.
- Salmonella typhi
- Shigella boydii
- Shigella dysenteriae
- Shigella flexneri
- Shigella sonnei
- Shigella sp.
- Aeromonas sp.
- Campylobacter sp.
- Clostridium sp.
- Plesiomonas sp.
- Vibrio cholera
- Vibrio parahaemolyticus
- Yersinia sp.
- CLProgramCoronavirus (SARS-CoV2) – ImmunologyCategoryClinical, Infectious Diseases, Internal Control, Proficiency Testing
- IgG
- IgM
- IgA
- Total
- IgM/IgA
- IgG Avidity
Immunology Automation by enzyme immunoassay, chemiluminescence, electrochemiluminescence, microparticles by chemiluminescence.
Related tests
Covid
- CLProgramCoronavirus (SARS-CoV2) – Molecular BiologyCategoryClinical, Genetics and Molecular Biology, Internal Control, Proficiency Testing
The program includes PCR-based molecular testing.
The samples contain the complete genome of the microorganism.Coronavirus (SARS-CoV2) – Molecular Biology
- Detection of SARS-CoV2¹ genes and identification of attention/concern.
- Sequencing: Coronavirus (SARS-CoV2)
Coronavirus (SARS-CoV2) – Molecular Biology: Saliva
- Detection of SARS-CoV21 genes.
Related exams
1Covid-19
- VETProgramCoronavirus (SARS-CoV2) – Molecular BiologyCategoryGenetics and Molecular Biology, Proficiency Testing, Veterinary
The program includes PCR-based molecular testing.
The samples contain the complete genome of the microorganism.- Detection of SARS-CoV2
- MICROProgramCoronavirus (SARS-CoV2) – Molecular BiologyCategoryFood, Microbiological, Proficiency Testing
This program is designed to detect the SARS-CoV2 genome in matrices simulating meat, meat products and other foods.
- CLProgramCoronavirus (SARS-CoV2): Antigen Search by AutomationCategoryClinical, Internal Control, Microbiology, Proficiency Testing
Coronavirus (SARS-CoV2): Antigen Search by Automation
Specific Program for Automation Systems.
- PCProgramCRM Brix Grade at 20 °CCategoryCertified Reference Materials, Physicochemical, Propriedade Ótica
CRM Brix Grade at 20 °C: 0,0 g/100 g
CRM Brix Grade at 20 °C: 12,0 g/100 g
CRM Brix Grade at 20 °C: 35,0 g/100 g
CRM Brix Grade at 20 °C: 49,0 g/100 g
CRM Brix Grade at 20 °C: 60,0 g/100 g - PCProgramCRM Buffer Solution for pHCategoryCertified Reference Materials, Ionic Activity, Physicochemical
CRM Buffer Solution for pH 1,7
CRM Buffer Solution for pH 4,0
CRM Buffer Solution for pH 6,9
CRM Buffer Solution for pH 9,2
CRM Buffer Solution for pH 10,0 - MRC Cloreto 1.000 mg/L
- MRC Cor 500 mg/L Pt-Co
- MRC Cianeto 1.000 mg/L
- PCProgramCRM Dissolved OxygenCategoryCertified Reference Materials, Physicochemical, Water & Environment
- MRC Oxigênio Dissolvido 0 mg/L
- PCProgramCRM Electrolytic Conductivity SolutionCategoryCertified Reference Materials, Ionic Activity, Physicochemical
CRM Electrolytic Conductivity Solution 1,50 µS/cm (1 iten) – MR013
CRM Electrolytic Conductivity Solution 5,00 µS/cm (1 iten) – MR014
CRM Electrolytic Conductivity Solution 25,00 µS/cm (1 iten) – MR004
CRM Electrolytic Conductivity Solution 50,00 µS/cm (1 iten) – MR007
CRM Electrolytic Conductivity Solution 100,0 µS/cm (1 iten) – MR001
CRM Electrolytic Conductivity Solution 500,0 µS/cm (1 iten) – MR006
CRM Electrolytic Conductivity Solution 1400 µS/cm (1 iten) – MR003
CRM Electrolytic Conductivity Solution 5000 µS/cm (1 iten) – MR005
CRM Electrolytic Conductivity Solution 12800 µS/cm (1 iten) – MR002 - MRC Fluoreto 1.000 mg/L
- MRC Ponto de Fusão 47 °C a 49 °C
- MRC Ponto de Fusão 69 °C a 71 °C
- MRC Ponto de Fusão 113 °C a 115 °C
- MRC Ponto de Fusão 121 °C a 123 °C
- MRC Ponto de Fusão 158 °C a 161 °C
- MRC Ponto de Fusão 164 °C a 166 °C
- PCProgramCRM Nitrate as NitrogenCategoryCertified Reference Materials, Physicochemical, Water & Environment
- MRC Nitrato como Nitrogênio 1.000 mg/L
- PCProgramCRM Nitrite as NitrogenCategoryCertified Reference Materials, Physicochemical, Water & Environment
- MRC Nitrito como Nitrogênio 1.000 mg/L
- PCProgramCRM OrthophosphateCategoryCertified Reference Materials, Physicochemical, Water & Environment
- MRC Ortofosfato 1000 mg/L
- ProgramCRM Qualitative Reference CulturesCategoryCertified Reference Materials, Microbiology, Reference Strains
Showing 1 to 94 of 94 entriesComply with the BrCAST recommendations
Comply with the CLSI recommendations
Nota 1: UKHSA licensed NCTC and CPF Strains are equivalent to the ATCC® strains referenced in this table.
Nota 2: Strains can be purchased separately or monthly with one, two or four units.
Nota 3: Strains not listed available on request. - MRC Potencial Redox 200,0 mV
- MRC Potencial Redox 229,0 mV
- MRC Potencial Redox 400,0 mV
- MRC Potencial Redox 476,0 mV
- PCProgramCRM Residual ChlorineCategoryCertified Reference Materials, Physicochemical, Water & Environment
- MRC Cloro Residual 1.000 mg/L
- MRC Salinidade 35 PSU
- MRC Sulfato 1.000 mg/L
- PCProgramCRM Total Dissolved SolidsCategoryCertified Reference Materials, Physicochemical, Water & Environment
-
- MRC Sólidos Dissolvidos Totais 1.000 mg/L
-
CRM Turbidity 4000 NTU
Crioglobulins1
Related test
1Cryoprecipitin
- VETProgramCryptococcus – Molecular BiologyCategoryGenetics and Molecular Biology, Proficiency Testing, Veterinary
The program includes PCR-based molecular testing.
The samples contain the complete genome of the microorganism.- Cryptococcus gattii
coli
Leia mais em Controllab: https://controllab.com/?post_type=product&p=51374&elementor-preview=51374&ver=1644597571 - Cryptococcus neoformans
- Cryptococcus spp.
- Cryptococcus gattii
- CLProgramCryptococcus neoformans – AntigenCategoryClinical, Clinical Microbiology, Internal Control, Proficiency Testing
- Research for Cryptococcus neoformans antigen in serum and CSF matrices
- CLProgramCSF – Automated Cell CountingCategoryBody Liquids, Clinical, Internal Control, Proficiency Testing
- Nucleated Cells
- Red Blood Cells
- HIV-1
- HIV-2
Cysticercosis – CSF – Immunology
- CSF Cysticercosis IgG
Cytomegalovirus – CSF – Immunology
- CSF Cytomegalovirus IgG
- CSF Cytomegalovirus IgM
Herpes – CSF – Immunology
- CSF Herpes I/II IgA
- CSF Herpes I/II IgG
- CSF Herpes I/II IgM
Syphilis – CSF – Immunology
- Syphilis IgG
- Syphilis IgM
- Syphilis Total
Toxoplasmosis – CSF – Immunology
- CSF Toxoplasmosis IgG
- CSF Toxoplasmosis IgM
Cerebrospinal Fluid I Assays
- Chlorides
- Glucose
- Total Proteins
Cerebrospinal Fluid II Assays
- Lactic Acid (Lactate)
- Adenosine Deaminase (ADA)
- Albumin (Assay)
- Oligoclonal Bands
- Chlorides
- Creatine
- Phosphokinase (CPK)
- Ferritin
- Glucose
- Immunoglobulin IgA
- Immunoglobulin IgG
- Immunoglobulin IgM
- IgG Index
- Lactate
- Dehydrogenase (LDH)
- Potassium
- Myelin Basic Protein
- Total Proteins
- Albumin Ratio
- Sodium
- AST/SGOT
- Urea
Cerebrospinal Fluid Global Cell Count
- Nucleated Cells
- Erythrocytes
Cellular Identification
- Cytology
- Basophils
- Eosinophils
- Lymphocytes
- Macrophages
- Monocytes
- Neutrophils
- Qualitative
- Observations
- Plasmocytes
- HTLV-1
- HTLV-2
- Bacilloscopy BAAR
- Bacterioscopy Gram
- Chinese Ink (Direct search for fungi)
Cystatin C
- CLProgramCytogenetics – G-Banding KaryotypeCategoryClinical, Genetics and Molecular Biology, Proficiency Testing
The program includes PCR-based molecular testing.
- G-Banding Karyotype – Constitutional
- G-Banding Karyotype – Fetal
- G-Banding Karyotype – Tumor
- Infectious Agents
- Cellular Changes
- Cellularity
- Malignancy Criteria
- Inflammatory Infiltrate
- Final Interpretation
- Qualitative Observations
- Cellular Types
- CLHEMOProgramCytomegalovirus – ImmunologyCategoryClinical, Hemotherapy, Infectious Diseases, Internal Control, Proficiency Testing
- CMV IgG
- CMV IgM
- IgG Avidity
Related Tests
- CMV
- Cytomegaly
- CLProgramCytomegalovirus – Molecular BiologyCategoryClinical, Genetics and Molecular Biology, Internal Control, Proficiency Testing
The program includes PCR-based molecular testing.
The samples contain the complete genome of the microorganism.- Detection of Cytomegalovirus (CMV).
D-Dimer
- VETProgramD-Dimer – CanineCategoryCoagulation / Haemostasis, Internal Control, Proficiency Testing, Veterinary
D-Dimer – Canine
Dengue I
- IgG
- IgM
- CLProgramDengue – Molecular BiologyCategoryClinical, Genetics and Molecular Biology, Internal Control, Proficiency Testing
The program includes PCR-based molecular testing.
The samples contain the complete genome of the microorganism.- Research – Dengue
- Serotypes – Dengue
Dengue II
- NS1
Related test
NS1 AntigenThe Proficiency Test is divided into two different programs according to the analytical systems served:
- Density I: Digital Densimeter
- Density II: Glass Hydrometer
- CLProgramDermatopathologyCategoryClinical, Pathological Anatomy / Cytopathology, Proficiency Testing
Dermatopathology
- 1.5 anhydroglucitol (1,5-AG)
- Free Fatty Acids
- Adiponectin
- Beta Hydroxybutyrate
- Total Ketone
- Gastrin
- Free and Total Insulin
- C-peptide
- Somatomedin A (IGF2)
- Anti-pancreatic islet antibodies (ICA)
- Anti-GAD
- Anti-insulin
- Anti-tyrosine phosphatase
- Anti-ZnT8
- CLProgramDiphtheria Bacillus Screening – MicroscopyCategoryClinical, Clinical Microbiology, Proficiency Testing
Diphtheria Bacillus Screening – Microscopy
- HEMOProgramDonor Selection – GeneralCategoryHematology / Hematoscopy, Hemotherapy, Immunohematology / Transfusion Medicine, Internal Control, Proficiency Testing
- Hematocrit (Automation)
- Hemoglobin
- Microhematocrit
- CLProgramDosage of GalactomannanCategoryClinical, Clinical Microbiology, Internal Control, Proficiency Testing
Dosage of Galactomannan
- CLProgramDrugs of Abuse – Hair and/or FurCategoryClinical, Occupational Toxicology / Abuse Drugs, Proficiency Testing
- 6-acetylcodéine
- 6-acetylmorphine
- Alprazolam
- Anfepramone (Diethylpropion)
- Amphetamine
- Benzoylecgonine
- Cannabidiol
- Cannabinol
- Ketamine
- Clonazepam
- Cocaethylene (cocaine + alcohol)
- Cocaine
- Codeine
- Crack (AEME)
- Diazepam
- Dihydrocodeine
- Ecstasy (MDMA)
- EDDP
- Ephedrine
- Femproporex
- Phencyclidine (PCP)
- Fentanyl
- Flunitrazepam
- Flurazepam
- Heroin
- Levamisole
- Lorazepam
- Marijuana (THC carboxylic acid)
- Marijuana (THC)
- Mazindol
- MBDB
- MDA
- MDEA
- Methadone
- Methamphetamine
- Midazolam
- Morphine
- Nitrazepam
- Norcocaine
- Nordiazepam
- Oxazepam
- Oxycodone
- Pethidine
- Temazepam
- Tramadol
- Zolpidem
- Zopiclone
- CLProgramDrugs of Abuse – SalivaCategoryClinical, Internal Control, Occupational Toxicology / Abuse Drugs, Proficiency Testing
- 6-acetylmorphine
- Alprazolam
- Amphetamine
- Benzoylecgonine
- Bromazepam
- Cannabidiol
- Cannabinol
- Clonazepam
- Cocaine
- Cocaethylene (cocaine + alcohol)
- Codeine
- Crack (AEME)
- Desmethyltramadol
- Diazepam
- Dihydrocodeine
- Ecstasy (MDMA)
- Fentanyl
- Flunitrazepam
- Flurazepam
- Hydrocodone
- Hydromorphone
- Ketamine
- Lorazepam
- Marijuana (THC)
- MBDB
- MDA
- MDEA
- Methadone
- Methamphetamine
- Midazolam
- Morphine
- Nitrazepam
- Norketamine
- Norcocaine
- Nordiazepam
- Norpropoxyphene
- Oxazepam
- Phencyclidine (PCP)
- Propoxyphene
- Temazepam
- Tramadol
• Dynamic Viscosity
Dynamic Viscosity (25°C)Effluent
Counting
- Sulfite Reducing Clostridia
- Thermotolerant Coliforms (45ºC)
- Enterococcus sp.
- Escherichia coli
- CLProgramElectrophoresis: LDHCategoryClinical, Clinical Chemistry, Internal Control, Proficiency Testing
Biochemistry I
- Albumin
- Adjusted Calcium
- Alkaline Phosphatase (ALP)
- Angiotensin-converting enzyme (ACE)
- CPK/CK (Creatinokinase)
- Creatinine
- Direct Bilirubin
- D-3-hydroxybutyrate
- Ferro
- gGT (Glutamyl Transferase Range)
- Glucose
- Glomerular Filtration Rate
- HDL cholesterol
- Indirect Bilirubin
- LDH (Total Lactic Dehydrogenase)
- LDH 1 (Dosage)
- Magnesium
- Phosphor
- Potassium
- PSA Total
- Sodium
- TGO/AST
- TGP/ALT
- Total Amylase
- Total Bile Acids
- Total Bilirubin
- Total Calcium
- Total cholesterol
- Total Proteins
- Triglycerides
- Urea
- Urea Nitrogen (BUN)
- Uric Acid
- VLDL cholesterol
Biochemistry II
- 5’Nucleotidase
- Aldolase
- Alpha Galactosidase
- Alpha Hydroxybutyrate Dehydrogenase (HBDH)
- Alpha-N-acetylglycosaminidase
- Biotinidase
- Chlorides
- Cholinesterase with Dibucaine Inhibition
- Citrate (Citric Acid)
- CK-MB Activity
- CK-MB Mass
- Cortisol
- Free Fatty Acids (NEFA)
- Free T3
- Free T4
- Frutosamine
- GLDH (Glutamate Dehydrogenage)
- Ionic Calcium
- Lactic Acid (Lactate)
- LDL cholesterol
- Leucinaminopeptidase (LAP)
- Lipase
- Lithium
- Non-Prostatic Acid Phosphatase
- Osmolality
- Pancreatic Amylase
- Phyanic Acid
- Plasma Cholinesterase
- Pristanic Acid
- Prostatic Acid Phosphatase (PAP)
- Salivary Amylase
- T3 Funding
- T3 Reverse
- T3 Total
- T4 Total
- Total Acid Phosphatase
- Total Iron Binding Capacity
Biochemistry III
- Baking soda
- Carbon Dioxide (CO2) Total
- D-xilose
Biochemistry IV
- Vitamin B1 (Thiamine)
- Vitamin B1 (Thiamine Monophosphate – TMP)
- Vitamin B1 (Total Thiamine)
- Vitamin B2 (Riboflavin)
- Vitamin B6 (Pyridoxine 5’phosphate – PLP)
Bioquímica V
- Vitamin B1 (Total Thiamine)
- Vitamin B1 (Thiamine Pyrophosphate – TPP)
- Vitamin B2 (Riboflavin)
- Vitamin B2 (Total Riboflavin)
- Vitamin B2 (Flavin Adenine Dinucleotide – FAD)
- Vitamin B2 (Flavin Mononucleotide)
- Vitamin B3 (Niacin)
- Vitamin B5 (Pantothenic Acid)
- Vitamin B6 (Pyridoxal 5’Phosphate – PLP)
- Vitamin B7 (Biotin)
Biochemistry VI
- Macroamilase
- Total Amylase
Biochemistry VII
- Mucoproteins (in Tyrosine)
- CLProgramEnterobacter – Molecular BiologyCategoryClinical, Genetics and Molecular Biology, Proficiency Testing
The program includes PCR-based molecular testing.
The samples contain the complete genome of the microorganism.- Enterobacter sp.
- Enterobacter aerogenes
- Enterobacter cloacae
- CLProgramEnterococcus – Molecular BiologyCategoryClinical, Genetics and Molecular Biology, Proficiency Testing
The program includes PCR-based molecular testing.
The samples contain the complete genome of the microorganism.- Enterococcus spp.
- Enterococcus faecalis
- Enterococcus faecium
- Enterococcus casseliflavus
- CLProgramEnterovirus – Molecular BiologyCategoryClinical, Genetics and Molecular Biology, Proficiency Testing
The program includes PCR-based molecular testing.
The samples contain the complete genome of the microorganism.- Enterovirus.
- Eosinophil Research – Feces
- Eosinophil Research – Nasal Mucus
- Eosinophil Research – Urine
- CLProgramEpidemiological Surveillance Cultures (ESC)CategoryClinical, Clinical Microbiology, Proficiency Testing
- Epidemiological Surveillance Cultures – Candida auris
Search for Candida auris
- Epidemiological Surveillance Culture Detection of Carbapenemases (CARBA)
Search for microorganisms resistant to carbapenems
- Epidemiological Surveillance Culture (ESBL)
Search for enterobacteria producing extended-spectrum betalactamases
- Epidemiological surveillance culture (GBS)
Group B streptococcus (GBS) test
- Epidemiological Surveillance Cultures – CAZ-AVI resistant microorganisms
Search for microorganisms resistant to CAZ-AVI
- Epidemiological Surveillance Culture (MRSA)
Testing for methicillin-resistant Staphylococcus aureus
- Epidemiological Surveillance Cultures – Polymyxin-resistant microorganisms
Search for polymyxin-resistant microorganisms
- Epidemiological Surveillance Culture (VRE)
Search for vancomycin-resistant enterococci
- CLProgramEpidemiological Surveillance MolecularCategoryClinical, Genetics and Molecular Biology, Proficiency Testing
Molecular Epidemiological Surveillance – Detection of Carbapenemases
- Genes resistance detection:
bla GES – like
bla IMP – like
bla KPC – like
bla NDM – like
bla OXA-143 – like
bla OXA-23 – like
bla OXA-48 – like
bla OXA-51 – like
bla OXA-72 – like
bla SPM – like
bla VIM – like
Molecular Epidemiological Surveillance (ESBL)
- Genes resistance detection:
bla CTXM-1 group
bla CTXM-2 group
bla CTXM-8 group
bla CTXM-9 group
bla SHV group
Molecular Epidemiological Surveillance (GBS)
- Group B Streptococcus Test
Molecular Epidemiological Surveillance (MRSA)
- Genes resistance detection:
MecA
MecC
Molecular Epidemiological Surveillance (VRE)
- Genes resistance detection:
VanA
VanB
- Genes resistance detection:
- CLProgramEpstein Barr – Molecular BiologyCategoryClinical, Genetics and Molecular Biology, Internal Control, Proficiency Testing
The program includes PCR-based molecular testing.
The samples contain the complete genome of the microorganism.- Epstein Barr
Related tests
Infectious Mononucleosis;
EBV, qualitative PCR
- CLProgramEpstein-Barr – ImmunologyCategoryClinical, Infectious Diseases, Internal Control, Proficiency Testing
- Epstein-Barr IgM
- Epstein-Barr Total
- Epstein-Barr Anti-VCA IgG
- Epstein-Barr Anti-VCA IgM
- VETProgramEquine HematologyCategoryHematology / Hematoscopy, Internal Control, Proficiency Testing, Veterinary
Tests included in Veterinary Hematology programs:
- Red blood cells
- Hemoglobin
- Hematocrit
- VCM
- HCM
- CHCM
- RDW
- Platelets
- VPM *
- PCT *
- PDW *
- Neutrophils *
- Lymphocytes *
- Monocytes *
- Eosinophils *
- Basophils *
- Granulocytes *
- MID *
- MXD *
- Leukocytes
* Tests offered as education.
- VETProgramEquine Infectious AnemiaCategoryInfectious Diseases, Internal Control, Proficiency Testing, Veterinary
Equine Infectious Anemia
Erythrocyte Dysmorphism Screening
- CLProgramErythrocyte Sedimentation Rate (ESR)CategoryClinical, Hematology / Hematoscopy, Internal Control, Proficiency Testing
Select an equipment
EP ESR is divided into 5 different programs according to the analytical systems served:
Erythrocyte Sedimentation Rate – Alifax: Alifax Systems
Erythrocyte Sedimentation Rate – General I: For Pipettes and Glass Tubes
Erythrocyte Sedimentation Rate – General II: Automation Systems (except Alifax, BC-780, and H550E), Pipettes, and Plastic Tubes (except Cralplast)
Erythrocyte Sedimentation Rate – General III: Cralplast Plastic Pipettes and Automation Systems (BC-780 and H550E)
Erythrocyte Sedimentation Rate – General IV: Wiener E32 System
<td
</tdESR – General I
ESR – General II ESR – General III ESR Fast Detector HumanSRate 24PT BC-780 Labor Import Humased 20/40 Cralplast Petrovacuum Labor Import H550E Seditainer Microsed System ESR – General IV Takives Mini-Ves Wiener E32 System Vacuplast Mix Rate X20 and X100 Westergren (Classic) Westergren Modified (Plastic Pipette) ESR – Alifax Wintrobe Seddi Pette Alifax Systems Sarstedt Sediplus S2000 and Sedivette (Manual) Vacuette Manual Tube and Pipette Vacuette SRT 10/II, SRS 20/II and SRS 100/II Ves-Matic Cube 30, 30 Touch, 80 and 200; Easy; Mini; Original 20, 20 Plus, 30 and 30 Plus; Track VHS Max VHS Timer Labor Impo
- CLProgramErythrovirus B19 – Molecular BiologyCategoryClinical, Genetics and Molecular Biology, Internal Control, Proficiency Testing
The program includes PCR-based molecular testing.
The samples contain the complete genome of the microorganism.- Detection of Erythrovirus B19.
- CLProgramEscherichia coli – Molecular BiologyCategoryClinical, Genetics and Molecular Biology, Proficiency Testing
The program includes PCR-based molecular testing.
The samples contain the complete genome of the microorganism.- Enteroaggregative Escherichia coli (EAEC)
- Enteropathogenic Escherichia coli (EPEC)
- Enterotoxigenic Escherichia coli (ETEC) LT/ST
- Escherichia coli O157
• Ethanol Fuel I
Total Acidity
Specific Mass (20ºC)
Alcohol Content
Water Content
Hydrocarbon content
Methanol content• Ethanol Fuel Conductivity
Conductivity (25ºC)• Ethanol Fuel pH
pH (25°C)- CLProgramEthanol Metabolite – HairCategoryClinical, Occupational Toxicology / Abuse Drugs, Proficiency Testing
- Ethylglucuronide (EtG)
- Ethylsulfate (EtS)
- CLProgramEthanol Metabolite – UrineCategoryClinical, Occupational Toxicology / Abuse Drugs, Proficiency Testing
- Ethylglucuronide (EtG)
- Ethylsulfate (EtS)
- CLProgramFactor V Leiden – Mutation ScreeningCategoryClinical, Genetics and Molecular Biology, Proficiency Testing
The program includes PCR-based molecular testing.
- Mutation Screening 1691G> A R506Q
- Mutation Screening H1299R
- Mutation Screening Y1702C
- CLProgramFecal Occult BloodCategoryClinical, Coprology / Occult Blood, Internal Control, Proficiency Testing
Fecal Occult Blood1
Related tests
1Fecal hemoglobin test
- VETProgramFeline HematologyCategoryHematology / Hematoscopy, Internal Control, Proficiency Testing, Veterinary
Tests included in Veterinary Hematology programs:
- Red blood cells
- Hemoglobin
- Hematocrit
- VCM
- HCM
- CHCM
- RDW
- Platelets
- VPM *
- PCT *
- PDW *
- Neutrophils *
- Lymphocytes *
- Monocytes *
- Eosinophils *
- Basophils *
- Granulocytes *
- MID *
- MXD *
- Leukocytes
* Tests offered as education.
** Legend I, II, III, IV, V and VI correspond to Feline Hematology I, Feline Hematology II, Feline Hematology III, Feline Hematology IV, Feline Hematology V and Feline Hematology VI.
Manufacturer Systems I II III IV V VI Abaxis VetScan HM5 X Abbott Cell Dyn 1600/ Dyn 3200 Ruby/ Dyn 3500/ Dyn 3700 X Bayer Advia 120 X Beckman Coulter Coulter GEN-S/ Série AC.T/ JT/ T890 X Bioeasy Bio 2900 X Bioclin Quibasa Hematoclin 2.8 Vet X Brasmed HemoVet 2300 X Bio Brasil VH20 X Boule Medical AB Exigo X Celm CC 510/ CC 530 X Diagno Icounter 3D/ Icounter Vet / Icounter VS X Diatron Abacus X Dymind DH 76/ DM61 VET X Edan Foco X3 Vet / H30 Vet X GENRUI KT-6200 Vet X Genius Hematoclin KT 6360 VET X GT Group Count 3000 X Hemogam Hemacounter 60 X Horiba ABX Micros 45 CRP/ 60/ ESV 60/ Pentra 120 X Horiba ABCvet X IDEXX LaserCyte Dx/ ProCyte Dx X In Vitro Human Humacount 30TS/ 80TS/ Plus X Labtest Aud-H Vet/ SDH 20/ SDH 3 Vet X MEDMAX Max Cel 200/ 300/ 500D/ 500D VET X Melet Schloesing MS4 X Mindray BC 30 Vet / BC 2800 / BC 2800 Vet / BC 3200 / BC 5000 / BC 5000 Vet / BC 5500 / BC 700 X Nihon Kohden Celltac MEK-6500 / Celltac MEK-6550 X Procan Electronics PE 6800 X Radim HeCo Plus X Shenzhen Tecom TEK-VET3 X Siemens Healthcare Advia 2120i X Toa Sysmex KX21N/ Poch 100i Vdiff/ XN-1000/ XP-300/ XS 800i/ XT 2000i/1800i X Urit 3000 Plus / 5160 / 5160 Vet / 5380 / 5380 Vet / BH-5100Vet / BH-70P / BH-70Vet X Wiener Counter 19 X Zybio EXC200 / VET3000/ Z51 Vet X - CLProgramFetal Sexing – Molecular BiologyCategoryClinical, Genetics and Molecular Biology, Proficiency Testing
The program includes PCR-based molecular testing.
- Cromosomo Y Screening
- CLProgramFirst Trimester Screening EvaluationCategoryClinical, Maternal-Fetal Medicine, Proficiency Testing
- Free BhCG
- PAPP-A (Pregnancy-Associated Plasma Protein)
• Fish: Determination of Total Volatile Bases
Determination of Total Volatile Bases• Fish: Total Fat
Total Fat• Fish: Histamine
Histamine• Fish: pH
pH• Fish: Hydrogen Sulphide Gas Test
Hydrogen Sulphide Gas Testing• Fish: Test for Ammonia
Test for AmmoniaFlour and similar
Bacteria count:
- Bacillus cereus
- Viable Aerobic Mesophilic Bacteria
- Molds and Yeasts
- Thermotolerant Coliforms (45°C)
- Total Coliforms (35°C)
- Escherichia coli
- Staphylococcus aureus
Search for:
- Salmonella spp.
Acute Leukemia Screening
- Identification of Immunophenotyping Population A and Immunophenotyping Population B
- CLProgramFlow Cytometry – Lymphocyte PanelCategoryClinical, Flow Cytometry, Internal Control, Proficiency Testing
- CD 2 +
- CD 3 +
- CD 3 + CD 4 +
- CD 3+ CD 8 +
- CD 3 – CD 56/16+
- CD 4 +
- CD 8 +
- CD 14 +
- CD 19 +
- CD 20 +
- CD 45 +
- CD 45 + CD 14
- CD 56 +
Related test
Lymphocyte Panel for Flow Cytometry
Flow Cytometry – PNH¹
Related Test
¹Paroxysmal nocturnal hemoglobinuria
- CLProgramFolic Acid – RBCCategoryClinical, Immunoassays / Endocrinology, Internal Control, Proficiency Testing, Releases
Folic Acid – RBC (Erythrocyte)
Food I
Counting of:
• Mesophilic Aerobes
• Bacillus cereus
• Molds and Yeasts
• Clostridium perfringens
Research of:
• Clostridium perfringens
• Listeria monocytogenes
• Salmonella spp.
• Salmonella enteritidis
• Salmonella typhimurium
Food II
Counting of:
• Thermotolerant Coliforms (45ºC)
• Total Coliforms (35ºC)
• Cronobacter spp.
• Enterobacteria
• Escherichia coli
• Staphylococcus Coagulase Positive
Determination of:
• Staphylococcal Enterotoxin
Research of:
• Cronobacter spp.
This program includes the search for specific IgG antibodies for 217 foods included in the food groups below:
- Meats
- Cereals and Grains
- Mushrooms
- Herbs and Spices
- Fruits
- Nuts and Seeds
- Vegetables
- Fish and Seafood
- Dairy and Eggs
- Greens and Vegetables
- Fruit Juice: Titratable Acidity
Total Titratable Acidity in citric acid - Fruit Juice: Ascorbic Acid
Ascorbic Acid - Fruit Juice: Total Sugars
Total Sugars - Fruit Juice: Density
Relative Density 20/20ºC
- Fruit Juice: pH
pH - Fruit Juice: Soluble Solids (ºBrix)
Soluble Solids (ºBrix) 20ºC - Fruit Juice: Sorbitol
Sorbitol
- Fruit Juice: Titratable Acidity
Lugol’s stain for identifying:
- Parasite
- Well-digested muscle fiber
- Connective tissue
- Crystal
- Raw Starch
- Digestible Cellulose
- Non-digestible cellulose
- Poorly Digested Muscle Fiber
Lugol, Methylene Blue and Panothic staining for identification of:
- Leukocyte
Gram stain for identifying:
- Yeast
Lugol and Sudam III staining for identification of:
- Neutral Fat
Screening for:
- Foreign bodies
- Plant Debris
- Reducing Bodies
- Bilirubin
- Stercobilin
- Degraded Proteins
- Non-degraded proteins
- Mucin
- Albumin
- pH(strip)
- Amino Acids and Ammonia
- Total Organic Acids
- Fats
Pancreatic Elastase
Alpha 1 – Antitrypsin
Coproporphyrins
Trypsin• Fusion Point
Fusion Point- Hematocrit
- Total Carbon Dioxide (CO2)
- pH
- pCO2
- pO2
Related Tests
Blood gases
- CLProgramGeneral ImmunohematologyCategoryClinical, Immunohematology / Transfusion Medicine, Internal Control, Proficiency Testing
- ABO and Rhesus – RH Systems
- Search for Extravascular Antibodies – Father (Indirect Coombs)
- HEMOProgramGeneral Immunohematology – HemotherapyCategoryHemotherapy, Immunohematology / Transfusion Medicine, Internal Control, Proficiency Testing
- ABO and Rhesus – RH Systems
- Search for Extravascular Antibodies – Father (Indirect Coombs)
- CLProgramGeneral Pathologic AnatomyCategoryClinical, Internal Control, Pathological Anatomy / Cytopathology, Proficiency Testing
General Pathologic Anatomy
- CLProgramGenetic Lactose IntoleranceCategoryClinical, Genetics and Molecular Biology, Proficiency Testing
The program includes PCR-based molecular testing.
The samples contain the complete genome of the microorganism.
- Mutation Search: 13910
- CLProgramGiárdia lamblia – AntigenCategoryClinical, Clinical Microbiology, Internal Control, Proficiency Testing
Giardia lamblia – Antigen
- CLProgramGiardia sp. – Molecular BiologyCategoryClinical, Genetics and Molecular Biology, Proficiency Testing
The program includes PCR-based molecular testing.
The samples contain the complete genome of the microorganism.- Detection of Giardia sp.
- VETProgramGiardia spp. – Molecular BiologyCategoryGenetics and Molecular Biology, Proficiency Testing, Veterinary
The program includes PCR-based molecular testing.
The samples contain the complete genome of the microorganism.- Giardia ssp.
- Giardia agilis
- Giardia ardeae
- Giardia microti
- Giardia muris
- Giardia psittaci
- VETProgramGiardia: Antigen TestCategoryClinical Microbiology, Internal Control, Proficiency Testing, Veterinary
Giardia: Antigen Test
- Glanders Elisa
- Glanders FC*
* Complement fixation test.
- CLProgramGlucose 6-Phosphate Dehydrogenase (G6PD)CategoryClinical, Clinical Chemistry, Proficiency Testing
Glucose 6-Phosphate Dehydrogebase (G6PD)
- VETProgramGlycated HemoglobinCategoryDiabetes / Hemoglobins, Internal Control, Proficiency Testing, Veterinary
- HbA1c
- CLProgramGlycated HemoglobinCategoryClinical, Diabetes / Hemoglobins, Internal Control, Proficiency Testing
The EP is divided into 2 different programs according to the analytical systems:
Glycated Hemoglobin I: All except those specified for Glycated Hemoglobin III.
Glycated Hemoglobin III: For Capillarys Electrophoresis Systems.
Tests:
- Hb A1
- Hb A1c
- VETProgramGram BacterioscopyCategoryClinical Microbiology, Internal Control, Proficiency Testing, Veterinary
- Gram Bacterioscopy
- CLProgramGRAM BacterioscopyCategoryClinical, Clinical Microbiology, Internal Control, Proficiency Testing
- GRAM Bacterioscopy
- CLProgramGroup A Streptococcus – Molecular BiologyCategoryClinical, Genetics and Molecular Biology, Proficiency Testing
The program includes PCR-based molecular testing.
The samples contain the complete genome of the microorganism.- Detection of group A Streptococcus by Molecular Biology.
- CLProgramGroup A Streptococcus (GAS): cultureCategoryClinical, Clinical Microbiology, Proficiency Testing
- Detection of group A Streptococcus by Molecular Biology.
- CLProgramGynecological CytologyCategoryClinical, Internal Control, Pathological Anatomy / Cytopathology, Proficiency Testing
Gynecological Cytology
- Hantavirus IgG
- Hantavirus IgM
HbS: Sickle Test¹
Related tests
¹Hemoglobin S – Sickle Test
¹Sickling test
¹Sickle cell
¹Solubility test
- CLProgramHBV – Molecular BiologyCategoryClinical, Genetics and Molecular Biology, Internal Control, Proficiency Testing
The program includes PCR-based molecular testing.
The samples contain the complete genome of the microorganism.- HBV-DNA
- CLProgramHCV – Molecular BiologyCategoryClinical, Genetics and Molecular Biology, Proficiency Testing
The program includes PCR-based molecular testing.
The samples contain the complete genome of the microorganism.- HCV-RNA Qualitative
- HCV-RNA Quantitative
- HCV Genotyping
Heinz Bodies Screening
- CLProgramHelicobacter pylori – AntigenCategoryClinical, Internal Control, Microbiology, Proficiency Testing
Helicobacter pylori – Antigen
- Helicobacter pylori IgG
- Helicobacter pylori IgA
- Helicobacter pylori IgM
- Total Helicobacter pylori
- CLProgramHelicobacter pylori – UreaseCategoryClinical, Clinical Microbiology, Internal Control, Proficiency Testing
Helicobacter pylori – Urease
- CLProgramHematology AutomationCategoryClinical, Hematology / Hematoscopy, Internal Control, Proficiency Testing
The tests contemplated:
Hematological Profile Tests Hematology Automation I Hematology Automation II Hematology Automation IV Hematology Automation V Red Series RBC Count, Hemoglobin, Hematocrit, MCV, MCH, MCHC and RDW, NRBC** X X X X Platelet Parameters Platelet Count X X X X MPV, PCT and PDW X* X* X* X* IPF (Immature Platelet Fraction) X* X* X* White Series Leukocyte Count X X X X Neutrophils, Lymphocytes, Monocytes, Eosinophils, Basophils, Granulocytes and MID X X X* *Tests offered as education
**Only in Hematology Automation IV
The EP is divided into 4 different programs according to the analytical systems served:
Note: The ‘Hematology Automation I’ program is general. The table below provides only a few examples of equipment covered in this program. Other systems not listed in the table should be included in the ‘Hematology Automation I’ program.
Brand Instrument I II IV V Abbott Cell Dyn Sapphire X Abbott Cell Dyn Ruby/1300/1400/1500/1600/1700/1800/3000/3200/3500/3700/4000/ Emerald 18/22 X Abbott Alinity hq X Alphatec Scientific 36/ 51/ 53pro/ 65pro X B&E Diagnostics Inc. Hemax 330 X Beckman Coulter DxH 500/520/560/800/900, CBS 5/ D2/ DN/ LH 500/750/755/780,GEN-S, HmX, JR, JT, MDII, MAXM, MD18, Onyx, AC.T, STKS, Série AC.T, T890, T540, T660, AcT Diff 2 X Biobase BK-6310/ 5000 X Bioclin Hematoclin 3.0/3.2/3.7/5.2/5.3/5.4/5.8 X Biotécnica Hemabio III / Hemabio V X Boule Swelab Alfa Plus X Celm CC510/530/550/ DA500/ HB520 X Diagno 5D/ I-counter 3D/ I-counter 3S X Diagon Dcell5D/60 X Diatron Abacus 380/3CT/5/Junior 30 X Dirui BCC-3900 / BF-6960 CRP / BF-7200 / BF-7200 Plus X Drew Scientific Drew-3 X DYMIND DF50/55 / DH21 / DH26 / DH36 / DH76 / DH615 / DH800 X Ebram EB3600/5500/5600/7600 / Medonic EB20 AutoSample/Classic/Plus X Erba Mannheim Elite 3/5/500/580/H360/H560 X Genius KT6200 X GT Group GT count 510/3000 X Horiba ABX Micros 45/CRP X Horiba ABX Micros 60/ES60, Pentra 60/80/80XL/ES60 X Horiba ABX Pentra 120/Retic/120 DF/DX/DX Nexus/XLR/ Yumizen H500/550/1500/2500 X In Vitro Humacount 30/60TS/80TS/5D/5L/Plus/ Blood 5P X Kovalent Mykov Cell 550/580 X LaborLab CHCEll 6019 X Labtest Labtest Aud H 5AL/ SDH3/5 X Labtest SDH 5/20 X LumiraDX Lumiratek-H5 X MEDMAX MAX CEL 200/300/500D/AUTO/620 X Melet Melet Schloesing MS4/ MS9 X Mindray BC5380/6000/6200/6800/6800Plus X Mindray BC10/20/20s/30/30s/700/720/760/780R/2300/2800/3000/3200/3600/5000
5130/5150/5180/5300/5500/5800/6000PlusX Neomedica Phoenix NCC-5500 X Nihon Kohden CellTac Alfa MEK6400/6410/6420/6500/ Es MEK7300K/ G MEK9100 X Norma Instruments Icon 3/5/5 op X Orpheè Mythic 18/22/22AL/22OT/60 X Rayto HA-86 (89) / Hemaray 86 / RT-7600 / 50CRP X SFRI H18 Light / Hemix 3-30 X Siemens Advia 60/120/360/560/2120/2120i/Atellica HEMA 580 X Sysmex K800/ K1000/ KX21N/ Poch 100i/ XE2100/ 2100D/ 5000/ XN1000/ 1500/ 2000/ 3000/ 3100/ 350/ 450/ 550/ 9000/ 9100/ XP300/ XQ-320/ XS800i/ 1000i/ XT1800i/ 2000i/ 4000i X Urit URIT 3000/Plus/5160/5200/5380/5500/ BH-70P/ BH-510 X Vida Biotecnologia Vida Count 380/510/860AL/3000 X Vyttra Hemacounter 60/SL X Wiener Counter 19/29/31AL/XS20 X Zybio Zybio EXZ 6000/Z3/Z5/Z31/Z50 X Related tests
Complete Blood Count (CBC)
- CLProgramHematology ManualCategoryClinical, Hematology / Hematoscopy, Internal Control, Proficiency Testing
- Date
- Hemoglobin
- Leukocytes
- Hematocrit (Microhematocrit)
- Red blood cells
- Platelets
Hematoscopy I
- Basophils
- Blasts (Immature Cells)
- Cell Identification
- Eosinophils
- Erythroblasts
- Lymphocytes
- Monocytes
- Neutrophil rods
- Neutrophils Metamyelocytes
- Neutrophils Myelocytes
- Other Conditions for Platelets
- Other Conditions for White Series
- Promyelocytes
- Red Series Morphology
- Segmented Neutrophils
Hematoscopy II
This program includes peripheral blood slides from patients with alterations that are less common in routine laboratories, such as cases of hematological neoplasms.- Basophils
- Blasts (Immature Cells)
- Eosinophils
- Erythroblasts
- Lymphocytes
- Monocytes
- Neutrophils
- Neutrophils
- Metamyelocytes
- Neutrophils Myelocytes
- Other Relevant Changes (Qualitative Evaluation): Red Series Morphology, Other Conditions for Platelets and White Series.
- Promyelocytes
- Segmented Neutrophils
- VETProgramHematoscopy and HemoparasitologyCategoryHematology / Hematoscopy, Proficiency Testing, Veterinary
Hematoscopy
- Basophils
- Neutrophils
- Blasts (Immature Cells)
- Eosinophils
- Lymphocytes
- Metamyelocytes Neutrophils
- Myelocytes Neutrophils
- Monocytes
- Promyelocytes Neutrophils
- Segmented Neutrophils
- Erythroblasts/100 Leukocytes
- Other Conditions
Hematoscopy – Identification of structures
Hemoparasitology (Identification)
- CLProgramHemochromatosis – Mutation ScreeningCategoryClinical, Genetics and Molecular Biology, Proficiency Testing
The program includes PCR-based molecular testing.
- Mutation Research C282Y
- Mutation Research H63D
- Mutation Research S65C
Hemocomponents
- Buffer Solution
- Deleukocytized Platelet Concentrate
- Deleukocytized RBC Concentrate
- Fresh Frozen Plasma
- Human Plasma
- Lyophilized Cryoprecipitate
- Platelet Concentrate
- Red Blood Cell Concentrate
- Scale (weight)*
- Transfer Bag
- Washed Red Blood Cell Concentrate
* This test is exclusive to blood collection scales.
AVAILABLE TESTS
Part I
- Degree of hemolysis
- Free Plasma Hemoglobin
- Hematocrit (Automation and Microhematocrit)
- Hemoglobin
- Leukocytes (Automated and Manual)
- Platelets (Automated and Manual)
- Residual Leukocyte
- Residual Platelet
- Residual Protein
- Residual Red Blood Cells
Part II
- pH (strip and automation)
- Scale (weight)
Part III
- Factor VIIIc
- Fibrinogen
- aPTT – sample/standard ratio
- aPTT – time
Microbiological analysis:
- Culture, Identification and Gram
Hemoglobin H¹ Screening
Related Exams
¹Alpha Thalassemia Screening; Hb H
- HEMOProgramHemoglobin SCategoryDiabetes / Hemoglobins, Hematology / Hematoscopy, Hemotherapy, Internal Control, Proficiency Testing
- Search for Hemoglobin S
- CLProgramHemoglobin SCategoryClinical, Diabetes / Hemoglobins, Internal Control, Proficiency Testing
- Search for Hemoglobin S
Proficiency Testing is divided into 2 different programs according to the methodology used for analysis:
- Hemoglobinopathies I: Chromatography
- Hemoglobinopathies II: Electrophoresis
Assays:
- Hemoglobin identification
- Hemoglobin quantification
Identification of Genus and Species.
- HEMOProgramHemotherapy SerologyCategoryHemotherapy, Infectious Diseases, Internal Control, Proficiency Testing
- Sorologia HBsAg
- Sorologia Anti-HBc
- Sorologia Anti-HBs
- Sorologia Anti-HCV
- Sorologia Anti-HIV
- Sorologia Anti-HTLV
- Sorologia Chagas
- Sorologia Sífilis
Related tests
- ¹Delta Hepatitis
- CLProgramHerpes – ImmunologyCategoryClinical, Infectious Diseases, Internal Control, Proficiency Testing
- Herpes IgG
- Herpes IgM
- Total Herpes
- CLProgramHerpes Virus – Molecular BiologyCategoryClinical, Genetics and Molecular Biology, Proficiency Testing
The program includes PCR-based molecular testing.
The samples contain the complete genome of the microorganism.- Herpes Virus Type 1/2
- Herpes Virus Type 1
- Herpes Virus Type 2
- CLProgramHistocompatibility: HLA TypificationCategoryClinical, Histocompatibility, Proficiency Testing
- High resolution
- Medium resolution
Class I
- HLA-A
- HLA-B
- HLA-C
Class II
- HLA-DRB1
- HLA-DQB1
- HLA-DPB1
- CLProgramHistoplasmosis – ImmunologyCategoryClinical, Immunology / Proteins, Infectious Diseases, Proficiency Testing
- M Band
- H Band
- Total Histoplasmosis
- CLProgramHIV – Molecular BiologyCategoryClinical, Genetics and Molecular Biology, Proficiency Testing
The program includes PCR-based molecular testing.
The samples contain the complete genome of the microorganism.HIV – Molecular Biology
- Quantitative HIV-RNA
- Genotyping
- Integrase Inhibitor Resistance Test (INSTI)
- Protease Inhibitor Resistance Test (PI)
- Nucleoside Reverse Transcriptase Inhibitor Resistance Test (NRTI)
- Non-nucleoside Reverse Transcriptase Inhibitor Resistance Test (NNRTI)
HIV: Whole Blood – Molecular Biology
- Qualitative HIV-cDNA
The program includes PCR-based molecular testing.
The samples contain the complete genome of the microorganism.HLA-B-27 Antigen1
Related tests
1HLAB27
-
Honey: Free Acidity and Total Acidity
Free acidity
Total acidity -
Honey: Ash
Ash (Fixed Mineral Residue) -
Honey: Color (Pfund Scale)
Pfund scale (mm) -
Honey: Hydroxymethylfurfural
Hydroxymethylfurfural -
Honey: pH
pH (25°C) -
Honey: Fiehe reaction
Fiehe reaction -
Honey: Lund reaction
Lund’s reaction -
Honey: Moisture
Moisture
-
- VETProgramHormonesCategoryImmunoassays / Endocrinology, Internal Control, Proficiency Testing, Veterinary
Hormones
- Aldosterone
- Erythropoietin
- Estradiol
- Free T4
- FSH
- Gastrin
- Glucagon
- Hypersensitive ACTH
- Insulin
- Osteocalcin
- Progesterone
- PTH (Intact)
- Somatomedin C (IGF-1)
- Total Cortisol
- Total T3
- Total T4
- TSH
- Vasopressin (ADH)
- CLProgramHormonesCategoryClinical, Immunoassays / Endocrinology, Internal Control, Proficiency Testing
- Hormones I
- 17OH Progesterone
- Androstenedione
- Androsterone
- Bioavailable Testosterone
- Cortisol
- DHEA
- DHEA sulphate (S-DHEA)
- Estradiol (E2)
- Estriol (EU3) Total
- Estriol (UE3) Free
- Estrone (E1)
- Free Androgen Index
- Free T3 (Triiodothyronine)
- Free Testosterone
- FSH (Follicle Stimulating Hormone)
- GH (Growth Hormone)
- Ghrelin
- HCG (Human Chorionic Gonadotrophin)/Beta HCG
- Homa Beta Index
- IR Homa Index
- Leptin
- LH (Luteinizing Hormone)
- Progesterone
- Prolactin
- SHBG (Sex Hormone Binding Globulin)
- T3 (Triiodothyronine) Total
- T3 (Triiodothyronine) Uptake
- T4 (Thyroxine) Free
- T4 (Thyroxine) Total
- Total Insulin
- Total Testosterone
- TSH (Thyroid Stimulating Hormone)
Hormones II
- ACTH (adrenocorticotrophic hormone)
- Erythropoietin (EPO)
Hormones III
- Initial Prolactin
- Macroprolactin
- Monomeric Prolactin
Hormones IV
- 11-Desoxycorticosterone (DOC)
- 11-Desoxycortisol (Compounds)
- 17 Hydroxy-pregnenolone
- 18 Hydroxycorticosterone
- 21-Deoxycortisol
- 3-Alpha Androstanediol Glycuronide (3-ALFA-DIOL)
- Corticosterone (Compound B)
- Cortisol Binding Globulin (CGB)
- Cortisone (Compound E)
- DHT (Dihydrotestosterone)
- GHBP
- Glucagon
- Inibin A
- Inibin B
- Insulin B
- Pregnenolone
- Pro-insulin
- Reverse T3 (Triiodothyronine)
- TBG (Thyroxine Binding Globulin)
Hormones VI
- AMH (Anti-Mullerian Hormone)
Hormones VII
- Intact PTH
- PTH – Related Protein
- PTH (1-84)
- CLProgramHPV – Nucleic Acid AmplificationCategoryClinical, Genetics and Molecular Biology, Proficiency Testing
The program includes PCR-based molecular testing.
The samples contain the complete genome of the microorganism.- Detection and genotyping of high-risk and low-risk HPV.
- CLProgramHPV – Signal AmplificationCategoryClinical, Genetics and Molecular Biology, Proficiency Testing
Detection of high-risk HPV and low-risk HPV by Hybrid Capture systems.
- CLProgramHTLV – Molecular BiologyCategoryClinical, Genetics and Molecular Biology, Internal Control, Proficiency Testing
El programa incluye técnicas moleculares basadas en la PCR.
Las muestras contienen el genoma completo del microorganismo.HTLV – Molecular biology
- HTLV-cDNA Quanti
HTLV: Whole Blood – Molecular Biology
- HTLV-cDNA Quali and Subtype
The PT is divided into 2 different programs according to the methodology used for analysis:
- Humidity I: Karl Fisher – Electrochemical/Amperometric
- Humidity II: Infrared and Direct Drying/Thermogravimetric
- CLProgramHypertension MarkersCategoryClinical, Clinical Chemistry, Immunoassays / Endocrinology, Proficiency Testing
- Aldosterone
- Angiotensin I
- Angiotensin II
- Angiotensin Converting Enzyme (ACE)
- Renina Activity
- Direct Renina
- Vasopressin (ADH)
- CLProgramImmuno-Histochemistry: BreastCategoryClinical, Pathological Anatomy / Cytopathology, Proficiency Testing
General Pathologic Anatomy
- CLProgramImmunofixation of Proteins – SerumCategoryClinical, Immunology / Proteins, Proficiency Testing
Immunofixation of Proteins – Serum
- CLProgramImmunohematology – AutomationCategoryClinical, Immunohematology / Transfusion Medicine, Internal Control, Proficiency Testing
- ABO and Rhesus System – Rh (D)
- Extravascular Antibody Survey – PAI (Indirect Coombs)
- Research of Intravascular Antibodies – TAD (Direct Coombs)
- CLProgramImmunohematology – ElutionCategoryClinical, Immunohematology / Transfusion Medicine, Proficiency Testing
- Direct Coombs Conclusion
- Elution
- IAI identification
- CLProgramImmunohematology Anti-A titrationCategoryClinical, Immunohematology / Transfusion Medicine, Internal Control, Proficiency Testing
- Titulação Anti-A
- HEMOProgramImmunohematology Anti-A titration – HemotherapyCategoryHemotherapy, Immunohematology / Transfusion Medicine, Internal Control, Proficiency Testing
- Titulação Anti-A
- CLProgramImmunohematology Anti-B titrationCategoryClinical, Immunohematology / Transfusion Medicine, Internal Control, Proficiency Testing
- Identificação de Anticorpos Irregulares – IAI
- HEMOProgramImmunohematology Anti-B titration – HemotherapyCategoryHemotherapy, Immunohematology / Transfusion Medicine, Internal Control, Proficiency Testing
- Identificação de Anticorpos Irregulares – IAI
- CLProgramImmunohematology Anti-D titrationCategoryClinical, Immunohematology / Transfusion Medicine, Internal Control, Proficiency Testing
- Anti-D titration
- HEMOProgramImmunohematology Anti-D titration – HemotherapyCategoryHemotherapy, Immunohematology / Transfusion Medicine, Internal Control, Proficiency Testing
- Anti-D titration
- HEMOProgramImmunohematology Automation – HemotherapyCategoryHemotherapy, Immunohematology / Transfusion Medicine, Internal Control, Proficiency Testing
- ABO and Rhesus System – Rh (D)
- Extravascular Antibody Survey – PAI (Indirect Coombs)
- Research of Intravascular Antibodies – TAD (Direct Coombs)
- CLProgramImmunohematology Cross-TestingCategoryClinical, Immunohematology / Transfusion Medicine, Proficiency Testing
- Cross-Testing
- HEMOProgramImmunohematology Cross-Testing – HemotherapyCategoryHemotherapy, Immunohematology / Transfusion Medicine, Proficiency Testing
- Cross-Testing
- HEMOProgramImmunohematology Elution – HemotherapyCategoryHemotherapy, Immunohematology / Transfusion Medicine, Proficiency Testing
- Direct Coombs Conclusion
- Elution
- IAI identification
- CLProgramImmunohematology IAICategoryClinical, Immunohematology / Transfusion Medicine, Internal Control, Proficiency Testing
- Identificação de Anticorpos Irregulares – IAI
- HEMOProgramImmunohematology IAI – HemotherapyCategoryHemotherapy, Immunohematology / Transfusion Medicine, Internal Control, Proficiency Testing
- Identificação de Anticorpos Irregulares – IAI
- CLProgramImmunohematology Phenotyping RH and KellCategoryClinical, Immunohematology / Transfusion Medicine, Internal Control, Proficiency Testing
- Antigens D, C, c, E, e, Cw, K, k, Kpa, Kpb
- RH system genotypes
- HEMOProgramImmunohematology Phenotyping RH and Kell – HemotherapyCategoryHemotherapy, Immunohematology / Transfusion Medicine, Internal Control, Proficiency Testing
- Antigens D, C, c, E, e, Cw, K, k, Kpa, Kpb
- RH system genotypes
- CLProgramImmunohematology TADCategoryClinical, Immunohematology / Transfusion Medicine, Proficiency Testing
- Intravascular antibody test – TAD (Coombs Direct)
- HEMOProgramImmunohematology TAD – HemotherapyCategoryHemotherapy, Immunohematology / Transfusion Medicine, Proficiency Testing
- Intravascular antibody test – TAD (Coombs Direct)
- CLProgramImmunosuppressant DrugsCategoryClinical, Internal Control, Proficiency Testing, Therapeutic Drugs Monitoring
Immunosuppressive Drugs I
- Azathioprine
- Cyclosporine
- Everolimus
- Sirolimus (rapamycin)
- Tacrolimus
Immunosuppressive Drugs II
- Mycophenolic Acid
- Dexamethasone
- Indican Test (Dysbiosis Test)
- CLProgramInfluenza A and B – Molecular BiologyCategoryClinical, Genetics and Molecular Biology, Internal Control, Proficiency Testing
The program includes PCR-based molecular testing.
- Detection of Influenza A and B.
- Interleukins 1 – beta
- Interleukins 6
- Interleukins 8
- Interleukins 10
- CLProgramJanus kinase 2 (JAK-2) – Mutation ScreeningCategoryClinical, Genetics and Molecular Biology, Proficiency Testing
The program includes PCR-based molecular testing.
- JAK-2 gene V617F mutation research.
Related tests
- Myeloproliferative Diseases
- JAK2 gene
- V617F gene
- Janus Kinase 2
- Polycythemia Vera
- Cystine
- Citrate (Citric Acid)
- Oxalate (Oxalic Acid)
- Sulfate
- Ammonium
- Calcium
- Carbonate
- Cystine
- Phosphate
- Magnesium
- Oxalate
- Urate
- CLProgramKlebsiella – Molecular BiologyCategoryClinical, Genetics and Molecular Biology, Proficiency Testing
The program includes PCR-based molecular testing.
The samples contain the complete genome of the microorganism.Detection by Molecular Biology of:
- Klebsiella sp.
- Klebsiella pneumoniae
- Klebsiella oxytoca
LE Cells Screening
- CLProgramLegionella – Molecular BiologyCategoryClinical, Genetics and Molecular Biology, Proficiency Testing
The program includes PCR-based molecular testing.
The samples contain the complete genome of the microorganism.Detection by Molecular Biology of:
- Legionella sp.
- Legionella pneumophila
Identification and Sensitivity Testing for Legionella pneumophila.
- VETProgramLeishmania – Molecular BiologyCategoryGenetics and Molecular Biology, Internal Control, Proficiency Testing, Veterinary
The program includes PCR-based molecular testing.
The samples contain the complete genome of the microorganism.Leishmania spp.
Leprosy
- Leptospirosis IgG
- Leptospirosis IgM
- CLProgramLeptospirosis – Molecular BiologyCategoryClinical, Genetics and Molecular Biology, Proficiency Testing
The program includes PCR-based molecular testing.
The samples contain the complete genome of the microorganism.- Detection of Leptospira spp.
- VETProgramLeptospirosis – Molecular BiologyCategoryGenetics and Molecular Biology, Proficiency Testing, Veterinary
The program includes PCR-based molecular testing.
The samples contain the complete genome of the microorganism.- Leptospira spp
- Leptospira interrogans
- Leptospira kirschneri
- Anti-Oxidized/Peroxidized LDL
- Apolipoprotein A-1
- Apolipoprotein A-2
- Apolipoprotein B (Apo B100)
- Apolipoprotein C-1
- Apolipoprotein C-2
- Apolipoprotein C-3
- Apolipoprotein E
- Cholesterol Esters
- Chylomicrons
- HDL Cholesterol
- LDL Cholesterol
- Lipoprotein (a)
- Phospholipids
- Total Cholesterol
- Triglycerides
- VLDL Cholesterol
Lipoprotein Electrophoresis
- Alpha (HDL)
- Pre-beta (VLDL)
- Beta (LDL)
- CLProgramLupus AnticoagulantCategoryClinical, Coagulation / Haemostasis, Internal Control, Proficiency Testing
Detection and interpretation of lupus anticoagulant using the following steps:
- Screening Test (Ratio) – DRVVT
- Mixture Test Screening (Ratio) – DRVVT
- Confirmatory Test (Ratio) – DRVVT
- Ratio (Screening/Confirmatory) – DRVVT
- Mixture Test Confirmatory (Ratio) – DRVVT
- Ratio (Mixture Screening/Mixture Confirmatory) – DRVVT
- Conclusion.
- CLProgramMayaro – Molecular BiologyCategoryClinical, Genetics and Molecular Biology, Proficiency Testing
The program includes PCR-based molecular testing.
The samples contain the complete genome of the microorganism.- Detection of Mayaro.
- CLProgramMeasles – ImmunologyCategoryClinical, Infectious Diseases, Internal Control, Proficiency Testing
- Measles IgG
- Measles IgM
• Meat Products: Starch and Carbohydrates
Starch (Quantitative)
Total Carbohydrates• Meat Products: Qualitative Starch
Starch (Qualitative)• Meat Products I
Ash (Fixed Mineral Residue)
Crude Protein
Moisture
Total Fat (GT)• Meat Products: pH (25°C)
pH (25°C)
• Meat Products: Ammonia Test
Test for Ammonia• Meat Products: Nitrite Test
Nitrite Test• Meat Products: Sulfite Test
Test for SulphiteMeat products I
Counting of:
• Clostridium perfringens
• Total Coliforms (35ºC)
• Thermotolerant Coliforms (45 ºC)
• Escherichia coli
• Staphylococcus aureus
Research of:
• Salmonella spp
• Salmonella enteritidis
• Salmonella typhimurium
Meat products II
Counting of:
• Viable Mesophilic Aerobic Bacteria
• Bacillus cereus
• Molds and Yeasts
• Enterobacteria
Research of:
• Listeria monocytogenes
- E. coli k1
- Haemophilus influenzae Tipo B
- Neisseria meningitidis A
- Neisseria meningitidis B
- Neisseria meningitidis C
- Neisseria meningitidis W135
- Neisseria meningitidis Y
- Streptococcus do grupo B
- S. pneumoniae
- CLProgramMetabolism Bone/Growth Markers – SerumCategoryClinical, Immunoassays / Endocrinology, Internal Control, Proficiency Testing
- 1,25 (OH)2 Vitamin D3 (Calcitriol)
- 25(OH) Vitamin D (Calcidiol)
- Alkaline Phosphatase (ALP) Bone Fraction
- Beta-carotene
- Intact Osteocalcin
- Osteocalcin N-Mid
- Total Osteocalcin
- P1NP (Type I Procollagen Propeptide)
- IGF Binding Protein 1 (IGFBP-1)
- IGF Binding Protein 2 (IGFBP-2)
- IGF Binding Protein 3 (IGFBP-3)
- Somatomedin C (IGF1)
- Telopeptide C(CTX)
- Telopeptide N (NTX)
- Vitamin A
- Vitamin E
- CLProgramMetabolism Bone/Growth Markers – UrineCategoryClinical, Internal Control, Proficiency Testing, Urinelysis
- C-Telopeptide (CTX)
- Deoxypyridinoline
- N-Telopeptide (NTX)
- Pyridinoline
- MICROProgramMicroorganisms on SurfacesCategoryMicrobiological, Proficiency Testing, Water & Environment
Microorganism Counts on Surfaces
• Aerobic Mesophilic Bacteria
• Mesophilic Aerobes
• Molds and Yeasts
Searching for Microorganisms on Surfaces
• Enterobacteriaceae
• Escherichia coli
• Pseudomonas aeruginosa
• Staphylococcus aureus
• Total Coliforms
• Milk – Somatic Cell Count
Somatic cell count (SCC)• Milk Powder
Fat
Lactose Reducing Glycides
Moisture
Protein
Reconstitution Test
Starch Identification
Titratable Acidity• Fluid Milk Ethanol Stability
Ethanol• Fluid Milk Identification: Starch
Starch• Fluid Milk Identification: Chlorides
Chlorides• Fluid Milk Identification: Chlorine/Hypochlorite
Chlorine/Hypochlorite• Fluid Milk Identification: Formaldehyde
Formaldehyde• Fluid Milk Identification: Alkaline Phosphatase
Alkaline Phosphatase• Fluid Milk Identification: Neutralizers
Neutralizers• Fluid Milk Identification: Peroxidase
Peroxidase Identification• Fluid Milk Identification: Hydrogen Peroxide
Hydrogen Peroxide• Fluid Milk Identification: Sucrose
Sucrose• Fluid Milk Quantitative I
Fat
Freezing Point (Cryoscopy)
Protein
Total Dry Extract (TDS)• Fluid Milk: Lactose Reducing Glycides
Lactose Reducing Glycides• Fluid Milk: Density
Density at 15ºC• Fluid Milk: Determination of Acidity
Acidity in Degrees Dornic
Titratable acidityMilk and Derivatives
Counting of:
- Bacillus cereus
- Total Coliforms(35ºC)
- Thermotolerant Coliforms(45ºC)
- Cronobacter spp.
- Enterobacteria.
- Escherichia coli
- Staphylococcus aureus
- Viable Mesophilic Aerobic Bacteria
Determination of:
- Staphylococcal Enterotoxins
Research of:
- Listeria monocytogenes
- Salmonella spp.
- CLProgramMolecular Panel for ArbovirusesCategoryClinical, Genetics and Molecular Biology, Internal Control, Proficiency Testing
The program includes PCR-based molecular testing for multiplex panels.
The samples contain the complete genome of the microorganism.
- Chikungunya
- Mayaro
- Oropouche Virus
- Yellow Fever
- Research – Dengue
- Serotypes – Dengue
- Yellow Fever
- Zika Virus
- CLProgramMolecular Panel for Bloodstream Infections and SepsisCategoryClinical, Genetics and Molecular Biology, Proficiency Testing
Pathogens
-
Acinetobacter baumannii
-
Bacteroides fragilis
-
Candida albicans
-
Candida glabrata
-
Candida krusei
-
Candida parapsilosis
-
Candida tropicalis
-
Candida spp.
-
Cryptococcus neoformans/gattii
-
Enterobacter cloacae
-
Enterobacteriaceae
-
Enterococcus spp.
-
Escherichia coli
-
Haemophilus influenzae
-
Klebsiella oxytoca
-
Klebsiella pneumoniae
-
Listeria monocytogenes
-
Morganella morganii
-
Neisseria meningitidis
-
Proteus spp.
-
Proteus spp./Morganella morganii
-
Pseudomonas aeruginosa
-
Salmonella spp.
-
Serratia marcescens
-
Staphylococcus aureus
-
Staphylococcus sp.
-
Streptococcus agalactiae
-
Streptococcus pneumoniae
-
Streptococcus pyogenes
-
Streptococcus spp.
Genes Resistentes
- MecA
- VanA
- VanB
- KPC
- SME
- NMC/IMI
- blaSHV
- bla CTX-M
- GES
- VIM
- GIM
- SPM
- NDM
- IMP3
- OXA-23
- OXA-24
- OXA-48
- OXA-51
- OXA-a58
-
- CLProgramMolecular Panel for Meningitis and EncephalitisCategoryClinical, Genetics and Molecular Biology, Proficiency Testing
The program includes PCR-based molecular testing for multiplex panels.
The samples contain the complete genome of the microorganism.- Adenovirus
- Cytomegalovirus (CMV)
- Cryptococcus gattii
- Enterovirus (EV)
- Epstein-Barr
- Eritrovirus B19
- Escherichia coli K1
- Haemophilus influenzae
- Herpes Virus type 1 (HSV-1)
- Herpes Virus type 2 (HSV-2)
- Herpes Virus type 6 (HSV-6)
- Herpes Virus type 7 (HSV-7)
- Listeria monocytogenes
- Neisseria meningitidis
- Parechovirus (HPeV)
- Streptococcus pneumoniae
- Streptococcus agalactiae
- Varicella-Zoster (VZV)
- Measles Virus
- CLProgramMolecular Panel for Respiratory Infections and PneumoniaCategoryClinical, Genetics and Molecular Biology, Internal Control, Proficiency Testing
The program includes PCR-based molecular testing for multiplex kits.
The samples contain the complete genome of the microorganism.- Adenovirus
- Bocavirus (HBoV)
- Bordetella bronchiseptica
- Bordetella parapertussis
- Bordetella pertussis
- Chlamydophila pneumoniae
- Coronavirus (SARS-CoV-2)
- Coronavirus 229E (COR229)
- Coronavirus HKU1 (HKU)
- Coronavirus NL63 (COR63)
- Coronavirus OC43 (COR43)
- Enterovirus (EV)
- Influenza A (H1N1-2009)
- Influenza A (H1N1)
- Influenza A (H3N2)
- Influenza B
- Legionella pneumophila
- Metapneumovirus A (HMPVA)
- Metapneumovirus A e B
- Metapneumovirus B (HMPVB)
- Mycoplasma pneumoniae
- Parainfluenza
- Parainfluenza 1
- Parainfluenza 2
- Parainfluenza 3
- Parainfluenza 4
- Parechovírus (HPeV)
- Rinovírus (RV)
- Sincicial Respiratory Virus A
- Sincicial Respiratory Virus A/B
- Sincicial Respiratory Virus B
- CLProgramMolecular Panel Gastrointestinal InfectionsCategoryAreas of Expertise, Clinical, Genetics and Molecular Biology, Proficiency Testing
The program includes PCR-based molecular testing for multiplex panels.
The samples contain the complete genome of the microorganism.Detection by Molecular Biology of:
- Adenovírus (AdV)
- Aeromonas spp.
- Astrovírus (AstV)
- Blastocystis hominis
- Cryptosporidium spp.
- Cyclospora cayetanensis
- Campylobacter spp.
- Clostridium difficile
- Clostridium difficile toxina B
- Clostridium difficile (cepa BI/NAP1/027)
- Dientamoeba fragilis
- E. coli enteroagregativa (EAEC)
- E. coli enteropatogênica (EPEC)
- E. coli enterotoxigênica (ETEC)
- E. coli O157
- E.coli produtora de toxina Shiga (STEC)
- Entamoeba histolytica
- Giardia lamblia
- Helicobacter pylori
- Norovírus (NoV)
- Plesiomonas shigelloides
- Rotavírus (RotV)
- Salmonella spp.
- Sapovírus
- Shigella spp.
- Shigella/E. coli enteroinvasora (EIEC)
- Vibrio cholerae
- Vibrio parahaemolyticus
- Vibrio spp.
- Vibrio vulnificus
- Yersinia enterocolítica
- CLProgramMolecular Panel STIs and VaginosisCategoryAreas of Expertise, Clinical, Genetics and Molecular Biology, Proficiency Testing
The program includes PCR-based molecular testing for multiplex panels.
The samples contain the complete genome of the microorganism.
- Atopobium vaginae
- Bacteria Associated with Bacterial Vaginosis 2 (BABV2)
- Bacteroides fragilis
- Candida albicans
- Candida dubliniensis
- Candida glabrata
- Candida krusei
- Candida lusitaniae
- Candida parapsilosis
- Candida tropicalis
- Chlamydia trachomatis
- Citomegalovírus
- Gardnerella vaginalis
- Haemophilus ducreyi
- Herpes Virus type 1 (HSV-1)
- Herpes Virus type 2 (HSV-2)
- Lactobacillus spp.
- Lymphogranuloma venereum
- Megasphaera Tipo 1
- Mobiluncus spp.
- Mycoplasma genitalium
- Mycoplasma hominis
- Neisseria gonorrhoeae
- Treponema pallidum
- Trichomonas vaginalis
- Ureaplasma parvum
- Ureaplasma urealyticum
- Varicella-Zoster
- VETProgramMpox – Molecular BiologyCategoryGenetics and Molecular Biology, Internal Control, Proficiency Testing, Veterinary
- Detection of Mpox by Molecular Biology.
- CLProgramMpox– Molecular BiologyCategoryClinical, Genetics and Molecular Biology, Internal Control, Proficiency Testing
The program includes PCR-based molecular testing.
The samples contain the complete genome of the microorganism.- Detection of Mpox (MPX)
- CLProgramMTHFR – Mutation ScreeningCategoryClinical, Genetics and Molecular Biology, Proficiency Testing
The program includes PCR-based molecular testing.
- Mutation Screening A1298C
- Mutation Screening C677T
- Mumps IgG
- Mumps IgM
Related test
- Parotitis
Mycobacteriology
- CLProgramMycobacterium tuberculosis – Molecular BiologyCategoryClinical, Genetics and Molecular Biology, Internal Control, Proficiency Testing
The program includes PCR-based molecular testing.
The samples contain the complete genome of the microorganism.- Detection of Mycobacterium tuberculosis by Molecular Biology.
- Amikacin Resistance Test (AMK)
- Capreomycin Resistance Test (CAP)
- Ethionamide Resistance Test (ETH)
- Fluoroquinolone Resistance Test (FLQ)
- Isoniazid Resistance Test (INH)
- Injectable Drug Resistance Test (SLID)
- Kanamycin Resistance Test (KAN)
- Rifampicin Resistance Test
- VETProgramMycobacterium tuberculosis – Molecular BiologyCategoryGenetics and Molecular Biology, Proficiency Testing, Veterinary
The program includes PCR-based molecular testing.
The samples contain the complete genome of the microorganism.- Mycobacterium tuberculosis.
- CLProgramMycobacterium tuberculosis (IFN-gamma) – ImmunologyCategoryClinical, Infectious Diseases, Proficiency Testing
- Mycobacterium tuberculosis – Negative
- Mycobacterium tuberculosis – Mitogenic
- Mycobacterium tuberculosis – Tuberculose
- Culture, identification and sensitivity test, filamentous and yeast-like fungi.
Mycology
- (Culture and Identification)
- CLProgramMycoplasma pneumoniae – ImmunologyCategoryClinical, Infectious Diseases, Internal Control, Proficiency Testing
- Mycoplasma IgA
- Mycoplasma IgG
- Mycoplasma IgM
- CLProgramMycoplasma pneumoniae – Molecular BiologyCategoryClinical, Genetics and Molecular Biology, Proficiency Testing
The program includes PCR-based molecular testing.The samples contain the complete genome of the microorganism.
- Mycoplasma pneumoniae
Myelogram
- HEMOProgramNAT – Molecular Biology ICategoryGenetics and Molecular Biology, Hemotherapy, Internal Control, Proficiency Testing
The program includes PCR-based molecular testing.
The samples contain the complete genome of the microorganism.- HCV
- HIV-1
- HEMOProgramNAT – Molecular Biology IICategoryGenetics and Molecular Biology, Hemotherapy, Internal Control, Proficiency Testing
The program includes PCR-based molecular testing.
The samples contain the complete genome of the microorganism.- Detection of NAT HBV.
- HEMOProgramNAT – MalariaCategoryGenetics and Molecular Biology, Hemotherapy, Proficiency Testing, Releases
The program includes PCR-based molecular testing.
The samples contain the complete genome of the microorganism.- Malaria Detection by NAT
- CLProgramNeisseria gonorrhoeae – Molecular BiologyCategoryClinical, Genetics and Molecular Biology, Internal Control, Proficiency Testing
The program includes PCR-based molecular testing.
The samples contain the complete genome of the microorganism.- Detection of Neisseria gonorrhoeae.
- Neisseria gonorrhoeae – Culture
- CLProgramNeonatal BilirubinCategoryClinical, Internal Control, Neonatal Diagnosis, Proficiency Testing
- Direct Bilirubin
- Indirect Bilirubin
- Total Bilirubin
- CLProgramNeonatal Screening – Infectious DiseasesCategoryClinical, Neonatal Diagnosis, Proficiency Testing
- Anti-Trypanossoma cruzi (Chagas)
- Anti-Cytomegalovirus IgM
- Anti-HIV
- Anti-Rubella IgM
- Anti-Toxoplasma IgM
- CLProgramNeonatal Screening – Screening for Acylcarnitine ProfileCategoryClinical, Neonatal Diagnosis, Proficiency Testing
Acylcarnitine Profile
- 3-OH-Butyrylcarnitine (C4-OH)
- 3-OH-Dodecanoylcarnitine(C12-OH)
- 3-OH-Stearoylcarnitine (C18-OH)
- 3-OH-Hexadecanoylcarnitine(C16-OH)
- 3-OH-Hexadecenoylcarnitine (C16:1-OH)
- 3-OH-Isovalerylcarnitine (C5-OH)
- 3-OH-Oleylcarnitine (C18:1-OH)
- 3-OH-Tetradecanoylcarnitine (C14-OH)
- Acetylcarnitine (C2)
- Adipylcarnitine (C6DC)
- Butyrylcarnitine (C4)
- Free Carnitine (CO)
- Decadienoylcarnitine (C10:2)
- Decanoylcarnitine (C10)
- Decenoylcarnitine (C10:1)
- Dodecanoylcarnitine (C12)
- Stearoylcarnitine (C18)
- Glutarylcarnitine (C5DC)
- Hexadecanoylcarnitine (C16)
- Hexadecenoylcarnitine (C16:1)
- Hexanoylcarnitine (C6)
- Isovalerylcarnitine (C5)
- Linoleoylcarnitine (C18:2)
- Malonylcarnitine (C3DC)
- Methylmalonylcarnitine (C4DC)
- Octanoylcarnitine (C8)
- Oleylcarnitine (C18:1)
- Propionylcarnitine (C3)
- Tetradecadienoylcarnitine (C14:2)
- Tetradecanoylcarnitine (C14)
- Tetradecenoylcarnitine (C14:1)
- Tiglylcarnitine (C5:1)
- CLProgramNeonatal Screening ICategoryClinical, Internal Control, Neonatal Diagnosis, Proficiency Testing
Neonatal Screening I
- 17OH Progesterone
- Phenylalanine (PKU)
- TSH Screening
- T4
Neonatal Screening – Trypsin
- Immunoreactive Trypsin
Neonatal Screening – Hemoglobins
- Hemoglobin Profile and Fractions: A1, A2, C, D, E, F and S
- CLProgramNeonatal Screening IICategoryClinical, Internal Control, Neonatal Diagnosis, Proficiency Testing
Amino acids
Amino acid tests and dosages:
- Alanine
- Arginine
- Argininosuccinic acid
- Citrulline
- Glycine
- Leucine
- Methionine
- Phenylalanine
- Tyrosine
- Valine
Biotinidase
- Screening and dosing
G6PD
- Dosage
Galactose
- Galactose Total
- Galactose-1-phosphate uridyl transferase
MCAD Deficiency
- Screening for MCAD Deficiency (Medium Chain Acetyl-Coenzyme A Dehydrogenase)
Lysosomal Diseases
- Acid alpha-glucosidase activity
- Acid Betaglycosidase Activity
- Alpha-Galactosidase A Activity
- Alpha-L-Iduronidase Activity
- CLProgramNeutralizing Antibody Screening: Coronavirus (SARS-CoV2)CategoryClinical, Infectious Diseases, Internal Control, Proficiency Testing
Neutralizing Antibody Screening: Coronavirus
Specific program for automation systems
- CLProgramNon Gynaecological Cytology – Liquids and BrushesCategoryClinical, Pathological Anatomy / Cytopathology, Proficiency Testing
Non Gynaecological Cytology – Liquids and Brushes
- CLProgramNon Gynaecological Cytology- Fine Needle Aspiration Cytology (FNAC)CategoryClinical, Pathological Anatomy / Cytopathology, Proficiency Testing
Non Gynaecological Cytology- Fine Needle Aspiration Cytology (FNAC)
Non-alcoholic Beverages
Bacterial count:
- Viable Aerobic Mesophilic Aerobic Bacteria
- Total Coliforms (35°C)
- Thermotolerant coliforms (45°C)
- Escherichia coli
- Molds and yeasts
Search for:
- Salmonella spp
- MICROProgramNon-sterile Pharmaceutical ProductsCategoryMicrobiological, Microbiology, Pharmaceutical Field, Proficiency Testing
These programs include tests for routine analysis of cosmetics and non-sterile medicines (oral and topical use).
Non-sterile Pharmaceutical Products I:
Count of:
- Total Aerobic Mesophilic Microorganisms.
- Viable Aerobic Mesophilic Bacteria.
Search for:
- Bile Tolerant Gram Negative Bacteria.
- Escherichia coli.
- Fecal Coliforms.
- Salmonella sp.
- Pseudomonas aeruginosa.
Non-sterile Pharmaceutical Products II:
Count of:
- Molds and Yeasts.
Search for:
- Candida albicans.
- Clostrídios.
- Clostrídios Sulfito Redutores.
- Clostridium perfringens
- Staphylococcus aureus.
Norovirus – Antigen
- VETProgramOccult BloodCategoryCoprology / Occult Blood, Internal Control, Proficiency Testing, Veterinary
Occult Blood
• Olive Oil: Specific Extinction
Specific Extinction (232nm)
Specific Extinction (270nm)• Oils and Fats: Soap Determination
Soap Determination• Oils and Fats: Acidity Index
Acidity Index• Oils and Fats: Iodine Index
Iodine Index• Oils and Fats: Peroxide Index
Peroxide Index• Oils and Fats: Refractive Index
Refractive Index• Oils and Fats: Saponification Index
Saponification Index• Oils and Fats: Kreis reaction
Kreis reaction• Oral Solution: Sodium Dipyrone
Identification
Content• Oral Solution: Paracetamol
Identification
Content- 2-Hydroxyvaleric Acid
- 3-Methylglutaric Acid
- Acetoxyacetic Acid
- Acid-2-Hydroxyglutaric
- Acid-3-Hydroxybutyric
- Adipic Acid
- Ethymalonic Acid
- Glutaric Acid
- Hydroxy-3-Methylglutaric Acid
- Hydroxyphenyl Lactic Acid
- Hydroxyphenyl Pyruvic Acid
- Keto 3-Methylvaleric Acid
- Ketoisocaproic Acid
- Ketoisovaleric Acid
- Lactic Acid
- Methylmalonic Acid
- Orotic Acid
- Pyruvic Acid
- Sebacic Acid
- Suberic Acid
- CLProgramOropouche Virus – Molecular BiologyCategoryClinical, Genetics and Molecular Biology, Proficiency Testing
The program includes PCR-based molecular testing.
The samples contain the complete genome of the microorganism.- Oropouche Virus Detection
- CLProgramOsmotic FragilityCategoryClinical, Hematology / Hematoscopy, Internal Control, Proficiency Testing
Interpretation of the hemolysis curve
Related tests
Globular Resistance
- Total Bilirubin
- Carboxyhemoglobin
- Total Hemoglobin
- Methemoglobin
- Oxyhemoglobin
- Reduced Hemoglobin (HHb)
- Oxygen Saturation (sO2)
- CLProgramParacoccidioidomycosis – ImmunologyCategoryClinical, Infectious Diseases, Proficiency Testing
- Total Paracoccidioidomycosis
- Parasitological identification (Canine)
- Parasitological identification (Equine)
- Parasitological identification (Feline)
- CLProgramParasitologyCategoryClinical, Coprology / Occult Blood, Internal Control, Proficiency Testing
Identification of intestinal parasites
- Parasitological identification
- CLProgramParentage Testing (Paternity/Maternity)CategoryClinical, Genetics and Molecular Biology, Proficiency Testing
The program includes PCR-based molecular testing.
The samples contain the complete genome of the microorganism.- Conclusion
- Parentage Testing Index
- Probability
- Parvovirus B19 IgG
- Parvovirus B19 IgM
- VETProgramPathological AnatomyCategoryPathological Anatomy / Cytopathology, Proficiency Testing, Veterinary
- Pathological Anatomy
- PCProgramPerfumesCategoryChemicals, Pharmaceutical Field, Physicochemical, Proficiency Testing, Releases
- Alcohol Content
- Density (20°C)
- pH (25°C)
• pH
pH (25ºC)Platelet Aggregation I
- Arachidonic Acid
- ADP
- Collagen
- Collagen/ADP
- Collagen/Epinephrine
- Conclusion
- Epinephrine (Adrenaline)
- Ristocetin
Platelet Aggregation II
- Arachidonic Acid
- ADP
- Collagen
- Conclusion
- Epinephrine (Adrenaline)
- Ristocetin
The Proficiency Test is divided into two different programs according to the matrix used for analysis:
- Platelet Aggregation I:Whole Blood
- Platelet Aggregation II: Platelet Rich Plasma (PRP)
- CLProgramPneumocystis jirovecii – MicroscopyCategoryClinical, Clinical Microbiology, Proficiency Testing
Pneumocystis jirovecii
Related tests
Pneumocystis jirovecii: Screening – microscopy
- CLProgramPOCT Adenovirus: AntigenCategoryClinical, Clinical Microbiology, Internal Control, Point of Care Testing (PoCT), Proficiency Testing, Releases
Adenovirus: Antigen
- CLProgramPOCT Anti-HBsCategoryClinical, Infectious Diseases, Internal Control, Point of Care Testing (PoCT), Proficiency Testing
POCT Anti-HBs
Related tests
¹Rapid Diagnostic Test – Anti-HBs
¹Rapid test Anti-HBs
- CLProgramPOCT Anti-HCVCategoryClinical, Internal Control, Point of Care Testing (PoCT), Proficiency Testing
POCT Anti-HCV¹
Related tests
¹Rapid Diagnostic Test Anti-HCV
¹Rapid Test Anti-HCV
- CLHEMOProgramPOCT Anti-HIVCategoryClinical, Hemotherapy, Infectious Diseases, Internal Control, Point of Care Testing (PoCT), Proficiency Testing
POCT Anti-HIV
Related Programs
Point of Care Testing – Anti-HIV
- CLProgramPOCT BiochemistryCategoryClinical, Internal Control, Point of Care Testing (PoCT), Proficiency Testing
POCT Biochemistry I
- Glucose
- Total Cholesterol
- Triglycerides
*The EP POCT Biochemistry I program is intended for systems that perform Total Cholesterol, Glucose and Triglyceride measurements concurrently on the same strip.
POCT Biochemistry II HDL
- HDL cholesterol
POCT Biochemistry IV
- Uric Acid
POCT Biochemistry V
- Albumin
- Alkaline Phosphatase
- Chloride
- Creatinine
- Direct Bilirubin
- Ferritin
- Gamma GT
- Glucose
- HDL Cholesterol
- LDL Cholesterol
- Ionic Calcium
- Magnesium
- Phosphorus
- Potassium
- Sodium
- TGO (AST)
- TGP (ALT)
- Total Bilirubin
- Total Cholesterol
- Total Protein
- Triglycerides
- Urea
- Uric Acid
- VLDL Cholesterol
POCT Biochemistry
- Folic Acid
- Lactic Acid
- Bile Acids
- Uric Acid
- ADA
- Albumin
- Aldolase
- Amylase
- Ammonia
- Beta carotene
- Direct Bilirubin
- Total Bilirubin
- Calcium
- Ketone
- CK-MB Activity
- CK-MB Mass
- Chloride
- Copper
- HDL Cholesterol
- Total Cholesterol
- CPK
- Creatinine
- Iron
- Prostatic Acid Phosphatase
- Total Acid Phosphatase
- Alkaline Phosphatase
- Phosphorus
- Fructosamine
- gGT
- Glucose
- LDH
- Lipase
- Total lipids
- Magnesium
- Potassium
- Total Proteins
- Sodium
- TGO/AST
- TGP/ALT
- Triglycerides
- Urea
- CLProgramPOCT BNPCategoryClinical, Internal Control, Point of Care Testing (PoCT), Proficiency Testing
- POCT BNP
Related tests
¹BNP remote laboratory test
¹Rapid BNP test
¹Brain natriuretic peptide - CLProgramPOCT Bone Metabolism/Growth Markers – SerumCategoryClinical, Immunoassays / Endocrinology, Internal Control, Point of Care Testing (PoCT), Proficiency Testing
- 25 (OH) Vitamin D
- CLProgramPOCT C-Reactive Protein – ImmunologyCategoryClinical, Internal Control, Point of Care Testing (PoCT), Proficiency Testing
- C-Reactive Protein – Immunology
Related tests
- Immunology – CRP
- Not ultrasensitive CRP
- CLProgramPOCT Cardiac PanelCategoryClinical, Internal Control, Point of Care Testing (PoCT), Proficiency Testing
POCT – Cardiac Panel¹
- CK-MB mass
- Myoglobin
- Troponin I
Related tests
¹Rapid Diagnostic Test – Cardiac Panel
¹Rapid Test of Cardiac Panel
- CLProgramPOCT ChagasCategoryClinical, Internal Control, Point of Care Testing (PoCT), Proficiency Testing
POCT Chagas¹
Related exams
¹Chagas remote laboratory test
¹Chagas quick test
¹Quick test Chagas disease
¹Quick trypanosomiasis test
- CLProgramPOCT Chikungunya – ImmunologyCategoryClinical, Internal Control, Point of Care Testing (PoCT), Proficiency Testing
- Chikungunya IgG
- Chikungunya IgM
- CLProgramPOCT Clostridium difficile – antigenCategoryClinical, Internal Control, Point of Care Testing (PoCT), Proficiency Testing
Clostridium difficile – Toxin A and B
- CLProgramPOCT Clostridium difficile – Toxin A and BCategoryClinical, Internal Control, Point of Care Testing (PoCT), Proficiency Testing
Clostridium difficile – Toxin A and B
- CLProgramPOCT CoagulationCategoryClinical, Coagulation / Haemostasis, Point of Care Testing (PoCT), Proficiency Testing
POCT – Coagulation¹
- TAP – Activity
- TAP – INR
- TAP – Time
- ACT – Activated Coagulation Time
- TTPa – Time
Related tests
¹Rapid Diagnostic Test – Coagulation
¹Rapid test of Coagulation
- CLProgramPOCT Coagulation IICategoryClinical, Coagulation / Haemostasis, Internal Control, Point of Care Testing (PoCT), Proficiency Testing
Program for systems only POCT¹
- Fibrinogen
- TAP – INR
- TAP – time
- Activated Coagulation Time (ACT)
- Thrombin Time (TT)
- TTPa – time
Related tests
¹Remote laboratory test Coagulation
¹Rapid coagulation test
- VETProgramPOCT Coagulation: CanineCategoryCoagulation / Haemostasis, Proficiency Testing, Veterinary
- Fibrinogen
- Thrombin Time (TT)
- Prothrombin Time (PT) – INR
- Prothrombin Time (PT) – time
- TTPa – time
- CLProgramPOCT Coronavirus (SARS-CoV2) – AntigenCategoryClinical, Internal Control, Microbiology, Point of Care Testing (PoCT), Proficiency Testing
POCT Coronavirus (SARS-CoV2)1: antigen I
Detection of SARS-CoV2 antigen by POCT in nasopharyngeal and oropharyngeal samples.POCT Coronavirus (SARS-CoV2): antigen II
Detection of SARS-CoV2 antigen by POCT in saliva samples.Related tests
1Covid
¹Rapid Diagnostic Test – Covid
¹Covid Rapid Test
- CLProgramPOCT Coronavirus (SARS-CoV2) – ImmunologyCategoryClinical, Infectious Diseases, Internal Control, Point of Care Testing (PoCT), Proficiency Testing
- Coronavirus (SARS-CoV2)1
- Coronavirus IgG
- Coronavirus IgM
- Coronavirus Total
POCT immunology by immunochromatography and immunofluorescence methods.
Related tests
1Covid
¹Rapid Diagnostic Test Covid
¹Rapid Test Covid
- ProgramPOCT Coronavirus (SARS-CoV2) – Molecular BiologyCategoryGenetics and Molecular Biology, Point of Care Testing (PoCT), Proficiency Testing
The program includes PCR-based molecular testing.
The samples contain the complete genome of the microorganism.- POCT Coronavirus (SARS-CoV2) Molecular Biology
- CLProgramPOCT Cystatin CCategoryClinical, Internal Control, Point of Care Testing (PoCT), Proficiency Testing
Cystatin C
- CLProgramPOCT D-DimerCategoryClinical, Coagulation / Haemostasis, Internal Control, Point of Care Testing (PoCT), Proficiency Testing
- POCT D-Dimer
- POCT D-Dimer Qualitative
Dengue
- IgG
- IgM
- CLProgramPOCT Dengue NS1CategoryClinical, Internal Control, Point of Care Testing (PoCT), Proficiency Testing
POCT Dengue NS1
- NS1
Related test
NS1 Antigen
- CLProgramPOCT Drug Abuse: UrineCategoryClinical, Internal Control, Occupational Toxicology / Abuse Drugs, Point of Care Testing (PoCT), Proficiency Testing
- Acetaminophen
- Amphetamine
- Amphetamine/Methamphetamine
- Antidepressant
- Barbiturates
- Benzodiazepines
- Cocaine
- Ecstasy (MDMA)
- Phencyclidine (PCP)
- Marijuana (carboxylic THC)
- Methadone
- Methamphetamine
- Methaqualone
- Morphine
- Opiates
- Oxycodone
- Propoxyphene
- CLProgramPOCT Ethanol Metabolite – UrineCategoryClinical, Occupational Toxicology / Abuse Drugs, Point of Care Testing (PoCT), Proficiency Testing
- Ethylglucuronide (EtG)
- CLProgramPOCT Gastrointestinal Infections: AntigenCategoryAreas of Expertise, Clinical, Genetics and Molecular Biology, Point of Care Testing (PoCT), Proficiency Testing, Releases
-
Cryptosporidium spp.
-
Entamoeba histolytica
-
Giardia lamblia
-
- CLProgramPOCT Giárdia lamblia – AntigenCategoryClinical, Internal Control, Point of Care Testing (PoCT), Proficiency Testing
Giardia lamblia – Antigen
Rapid Diagnostic Test – Glucose¹
Related exams
¹Remote laboratory test Glucose
¹Glucose Quick Test
- CLProgramPOCT GlucoseCategoryClinical, Internal Control, Point of Care Testing (PoCT), Proficiency Testing
Exclusive program for single devices that only measure glucose (glucometers).
POCT Glucose¹
Related tests
¹Rapid Diagnostic Test – Glucose
¹Rapid Test of Glicose
- CLProgramPOCT Glycated HemoglobinCategoryClinical, Diabetes / Hemoglobins, Internal Control, Point of Care Testing (PoCT), Proficiency Testing
The EP is divided into 3 different programs according to the analytical systems:
POCT Glycated Hemoglobin I: For all POCTs except Glycated Hemoglobin II and IV POCTs.
POCT Glycated Hemoglobin II: For Eco, Hilab, Lumirateck and Nycocard POCT systems.
POCT Glycated Hemoglobin IV: For AFIAS and Ichroma POCT Systems
Tests:
- Hb A1c
- CLProgramPOCT HBsAgCategoryClinical, Infectious Diseases, Internal Control, Point of Care Testing (PoCT), Proficiency Testing
POCT – HBsAg¹
Related tests
¹Rapid Diagnostic Test – HBsAg
¹Rapid Test of HBsAg
- CLProgramPOCT HCG – SerumCategoryClinical, Internal Control, Point of Care Testing (PoCT), Proficiency Testing
POCT – HCG
- Serum
Related tests
¹Rapid Diagnostic Test HCG
¹Rapid test of HCG
- CLProgramPOCT HCG – UrineCategoryClinical, Internal Control, Point of Care Testing (PoCT), Proficiency Testing
POCT – HCG
- Urine
Related tests
¹Rapid Diagnostic Test HCG
¹Rapid test of HCG
- CLProgramPOCT Helicobacter pylori – AntigenCategoryClinical, Internal Control, Point of Care Testing (PoCT), Proficiency Testing
Helicobacter pylori – Antigen
- CLProgramPOCT HematologyCategoryClinical, Internal Control, Point of Care Testing (PoCT), Proficiency Testing
Exclusive program for single-use devices and/or those that include capillary blood collection:
POCT Hematology¹
- Red Series
- Platelet Parameters
- White Series
Relative tests
¹Remote laboratory test Hematology
¹Rapid test Hematology
- CLProgramPOCT HemoglobinopathiesCategoryClinical, Diabetes / Hemoglobins, Point of Care Testing (PoCT), Proficiency Testing
- Hemoglobin identification
- CLProgramPOCT HormonesCategoryClinical, Internal Control, Point of Care Testing (PoCT), Proficiency Testing
POCT Hormones¹
- Cortisol
- Estradiol
- FSH
- LH
- Progesterone
- Prolactin
- T3 Total
- T4 Total
- T4 Free
- Total Testosterone
- TSH
Related tests
¹Hormones remote laboratory test
¹Rapid hormone test
POCT Hormones AMH
- AMH
- CLProgramPOCT ImmunohematologyCategoryClinical, Immunohematology / Transfusion Medicine, Internal Control, Point of Care Testing (PoCT), Proficiency Testing, Releases
- Rh(D) factor
- Blood Group
- CLProgramPOCT Influenza A and BCategoryClinical, Internal Control, Point of Care Testing (PoCT), Proficiency Testing
POCT – Influenza A and B¹
Related tests
¹Rapid Diagnóstic Test – Influenza A and B
¹Rapid test of Influenza A and B
- CLProgramPOCT KetoneCategoryClinical, Diabetes / Hemoglobins, Point of Care Testing (PoCT), Proficiency Testing
POCT Ketone¹
Related tests
Ketone Remote Laboratory Test¹
Ketone Rapid Test¹
- CLProgramPOCT LactoferrinCategoryClinical, Internal Control, Point of Care Testing (PoCT), Proficiency Testing
Lactoferrin
- CLProgramPOCT Legionella pneumophila – AntigenCategoryClinical, Point of Care Testing (PoCT), Proficiency Testing
POCT Legionella pneumophila – Antigen
Related tests
¹Remote laboratory test Legionella pneumophila – Antigen
¹Rapid Legionella pneumophila – Antigen test
- CLProgramPOCT Leptospirosis – ImmunologyCategoryClinical, Point of Care Testing (PoCT), Proficiency Testing
- Leptospirosis IgG
- Leptospirosis IgM
- CLProgramPOCT M. tuberculosis complex: antigenCategoryClinical, Internal Control, Point of Care Testing (PoCT), Proficiency Testing
- Research into the MPT64 protein of the Mycobacterium tuberculosis complex.
POCT Malaria – Antigen
- Plasmodium falciparum
- Non-falciparum Plasmodium
- CLProgramPOCT Molecular Influenza A and BCategoryClinical, Genetics and Molecular Biology, Proficiency Testing
The program includes PCR-based molecular testing.
The samples contain the complete genome of the microorganism.- POCT Molecular Influenza A and B.
- CLProgramPOCT Molecular Respiratory Syncytial Virus (RSV)CategoryClinical, Genetics and Molecular Biology, Internal Control, Proficiency Testing
The program includes PCR-based molecular testing.
The samples contain the complete genome of the microorganism.- POCT Molecular Respiratory Syncytial Virus
- CLProgramPOCT NT-proBNPCategoryCardiac Markers, Clinical, Internal Control, Point of Care Testing (PoCT), Proficiency Testing, Releases
- NTproBNP
- CLProgramPOCT Panel for Respiratory InfectionsCategoryClinical, Internal Control, Point of Care Testing (PoCT), Proficiency Testing
POCT Panel for Respiratory Infections
- Coronavirus (SARS-CoV2): antigen
- POCT Influenza A and B
- POCT Respiratory Syncytial Virus (RSV)
- CLProgramPOCT Premature Rupture of MembranesCategoryClinical, Point of Care Testing (PoCT), Proficiency Testing
- PAMG-1
- IGFBP-1
- CLProgramPOCT ProcalcitoninCategoryClinical, Hospitals, Immunoassays / Endocrinology, Internal Control, Point of Care Testing (PoCT), Proficiency Testing
Procalcitonin1
Related Tests
1PCT
- CLProgramPOCT Respiratory Syncytial Virus (RSV)CategoryClinical, Internal Control, Point of Care Testing (PoCT), Proficiency Testing
TLR Respiratory Syncytial Virus (RSV)¹
Related tests
¹Remote RSV laboratory test
¹Rapid RSV test
- CLProgramPOCT Search for Neutralizing Antibodies: Coronavirus (SARS-CoV2)CategoryClinical, Infectious Diseases, Internal Control, Point of Care Testing (PoCT), Proficiency Testing
Search for Neutralizing Antibodies: Coronavirus (SARS-CoV2)
Specific program for Point of Care systems.
- CLProgramPOCT Streptococcus group A – AntigenCategoryClinical, Internal Control, Microbiology, Point of Care Testing (PoCT), Proficiency Testing
POCT Streptococcus group A – Antigen¹
Related tests
¹Rapid Diagnostic Test Streptococcus group A – Antigen
- CLProgramPOCT SyphilisCategoryClinical, Infectious Diseases, Internal Control, Point of Care Testing (PoCT), Proficiency Testing
POCT Syphilis¹
Related tests
¹Rapid Diagnostic Test – Syphilis
¹Rapid Test of Syphilis
- CLProgramPOCT Troponin TCategoryClinical, Internal Control, Point of Care Testing (PoCT), Proficiency Testing
Troponin T
- CLProgramPOCT Tumor MarkersCategoryClinical, Immunoassays / Endocrinology, Internal Control, Point of Care Testing (PoCT), Proficiency Testing
POCT – Tumor Markers I¹
- Beta-2-microglobulin
- CEA
- Free PSA
- PSA Total Quali
- PSA Total Quanti
Related tests
¹Rapid Diagnostic Test – Tumor Markers
¹Rapid Test of Tumor Markers
POCT – Tumor Markers II
- Alpha fetoprotein
- CLProgramPOCT Urine BiochemistryCategoryClinical, Internal Control, Point of Care Testing (PoCT), Proficiency Testing
- Albumin
- Creatinine
- CLProgramPOCT Yellow Fever – ImmunologyCategoryClinical, Point of Care Testing (PoCT), Proficiency Testing
- Yellow fever IgG
- Yellow fever IgM
- CLProgramPOCT Zika Virus – ImmunologyCategoryClinical, Internal Control, Point of Care Testing (PoCT), Proficiency Testing
- Zika Virus IgG
- Zika Virus IgM
- CLProgramPolyomavirus – Molecular BiologyCategoryClinical, Genetics and Molecular Biology, Proficiency Testing
The program includes PCR-based molecular testing.
The samples contain the complete genome of the microorganism.- BK Polyomavirus
- JC Polyomavirus
- Porphobilinogen (PBG)
- Coproporphyrin I
- Coproporphyrin III
- Total Coproporphyrin
- Heptaporphyrin
- Hexaporphyrin
- Pentaporphyrin
- Total Porphyrins
- Uroporphyrin
- PLGF (Placental Growth Factor)
- sFLT-1 (Soluble Tyrosine Kinase)
- sFlt-1 / PLGF ratio
- CLProgramPremature Rupture of Membranes: Fern TestCategoryClinical, Maternal-Fetal Medicine, Proficiency Testing
- Fern Test
- CLProgramProcalcitoninCategoryClinical, Hospitals, Immunoassays / Endocrinology, Internal Control, Proficiency Testing
Procalcitonin1
Related Tests
1PCT
- CLProgramProtein Electrophoresis – Cavity FluidsCategoryBody Liquids, Clinical, Proficiency Testing, Releases
Protein Electrophoresis
- Albumin
- Albumin (Dosage)
- Alpha I
- Alpha II
- Beta
- Beta I
- Beta II
- Gamma
- Prealbumin
- Total Proteins
- (Dosage)
- CLProgramProtein Electrophoresis: UrineCategoryClinical, Internal Control, Proficiency Testing, Urinelysis
Protein Electrophoresis:
- Albumin
- Alpha I
- Alpha II
- Beta
- Gamma
- Total Proteins
- CLProgramProtein Immunofixation – UrineCategoryClinical, Immunology / Proteins, Internal Control, Proficiency Testing
Protein Immunofixation – Urine
- CLProgramProthrombin – Mutation ScreeningCategoryClinical, Genetics and Molecular Biology, Proficiency Testing
Prothrombin – Mutation Screening
Related Exams
Factor II – Mutation
- PCProgramPurified Water and InjectablesCategoryInternal Control, Pharmaceutical Field, Physicochemical, Proficiency Testing
• Water I – Purified and Injectable
Acidity / Alkalinity
Oxidizable Organic Substances – Quali
Silicates – Quali
Free Residual Chlorine – Quali• Purified Water and Injectables – TOC
Total Organic Carbon (TOC) These programs includes tests for the routine analysis of seawater, effluents and untreated recreational water (from rivers, lakes, waterfalls).
Raw Water I
Counting of:
• Escherichia coli
• Heterotrophic Bacteria
• Pseudomonas aeruginosa
• Thermotolerant Coliform (45 ºC)
• Total Coliform (35°C)Raw Water II
Counting of:
• Enterococcus spp
• Sulphite Reducing Clostridia
• Staphylococcus aureus- Reducing Substances Screening
MicrorganismoBrCAST/CLSIMRC ISO 17034
NCTC®/NCPF®WDCMATCC®Modelo de CertificadoFicha TécnicaAcinetobacter baumannii 
12156 — 19606 Model Ficha Acinetobacter baumannii 
13304 — — Model Ficha Aeromonas hydrophila 
12902 — 35654 Model Ficha Alcaligenes faecalis 
12904 — 35655 Model Ficha Aspergillus brasiliensis 
2275 WDCM 00053 16404 Bacillus cereus 
10320 WDCM 00001 11778 19637/ 9634 Model Ficha Bacillus pumilus 10327 — 27142 Bacillus subtilis 
10400 WDCM 00003 6633 Model Ficha Bacteroides distasonis 11152 — 8503 Bacteroides fragilis 
9343 — 25285 Model Ficha Bacteroides ovatus 11153 — 8483 Bacteroides vulgatus 11154 — 8482 Burkholderia cepacia 
10743 — 25416 Model Ficha Campylobacter jejuni 
11351 — 33560 Model Ficha Campylobacter jejuni 
13367 WDCM 00005 33291 Model Ficha Candida albicans 
3179 WDCM 00054 10231 Candida albicans 
3255 WDCM 00055 2091 Candida albicans 
3939 — 90028 Citrobacter freundii 
9750 — 8090 Clostridium bifermentans 
506 WDCM 00079 — Clostridium difficile 
13566 — 43593 Clostridium perfringens 
8237 WDCM 00007 13124 / 19408 Model Ficha Clostridium perfringens 
13170 WDCM 00201 — Model Ficha Clostridium septicum 
547 — 12464 Clostridium sordellii 13356 — 9714 Clostridium sporogenes 
532 WDCM 00008 19404 Ficha Clostridium sporogenes 
12935 — 11437 Model Ficha Corynebacterium pseudodiphtheriticum 11136 — 10700 / 7091 Corynebacterium renale 7448 — 19412 Cronobacter sakazakii 
11467 WDCM 00214 29544 Model Ficha Edwardisiella tarde 10396 — 15947 / 23656 Enterobacter cloacae 
10005 WDCM 00083 13047 Model Ficha Enterobacter hormaechei 
13870 — 700323 Enterococcus faecalis 
775 WDCM 00009 19433 Model Ficha Enterococcus faecalis 
12697 WDCM 00087 29212 Model Ficha Enterococcus faecalis 
13379 WDCM 00085 00152 51299 Model Ficha Enterococcus faecalis 
13763 WDCM 00210 33186 Model Ficha Enterococcus faecium 
12202 — — Model Ficha Enterococcus hirae 
13383 WDCM 00011 10541 Escherichia coli 
9001 WDCM 00090 /WDCM 00155 11775 Ficha Escherichia coli 
11954 — 35218 Model Ficha Escherichia coli 
12241 WDCM 00013 25922 Model Ficha Escherichia coli 
12900 WDCM 00014 700728 Model Ficha Escherichia coli 
13216 WDCM 00202 — Model Ficha Escherichia coli 
13352 — — Escherichia coli 
13353 — — Model Ficha Escherichia coli 
13476 — — Model Ficha Escherichia coli 
13384 — 11229 Escherichia coli 
13846 — — Model Ficha Escherichia coli 
12923 WDCM 00012 / 00196 8739 Model Ficha Fluoribacter bozemanae 11368 — 33217 Haemophilus influenzae 
8468 — 9334 Model Ficha Haemophilus influenzae 
8469 — — Haemophilus influenzae 
12699 — 49247 Model Ficha Haemophilus influenzae 
12975 — 49766 Model Ficha Haemophilus influenzae 
13377 — — Model Ficha Klebsiella aerogenes 
10006 WDCM 00175 13048 Model Ficha Klebsiella oxytoca 8167 — — Klebsiella pneumoniae 
9633 WDCM 00097 13883 Model Ficha Klebsiella pneumoniae 
13368 — 700603 Model Ficha Klebsiella pneumoniae 
13438 — — Model Ficha Klebsiella pneumoniae 
13440 — — Model Ficha Klebsiella pneumoniae 
13442 — — Model Ficha Klebsiella pneumoniae 
13443 — — Model Ficha Klebsiella pneumoniae 
13809 — BAA 1705 Model Ficha Kocuria rhizophila 8340 — 9341 Legionella pneumophila 
11192 WDCM 00107 33152 Legionella pneumophila 
12821 WDCM 00205 — Listeria innocua 
11288 WDCM 00017 33090 Model Ficha Listeria monocytogenes 
11994 WDCM 00019 — Model Ficha Listeria monocytogenes 
13372 — 7644 Model Ficha Listeria monocytogenes 
13627 WDCM 00020 19111 Model Ficha Micrococcus luteus 
7743 — 10240 Mycobacterium smegmatis 
8159 — 19420 Neisseria gonorrhoeae 
8375 — 19424 Model Ficha Neisseria gonorrhoeae 
12700 — 49226 Model Ficha Pasteurella multocida 10322 — 43137 Propionibacterium acnes 737 — 6919 Proteus mirabilis 11938 WDCM 00023 29906 Proteus vulgaris 4175 — 13315 Providencia alcalifaciens 10286 — 9886 Pseudomonas aeruginosa 
10662 WDCM 00114 25668 Model Ficha Pseudomonas aeruginosa 
12903 WDCM 00025 27853 Model Ficha Pseudomonas fluorescens 
10038 WDCM 00115 13525 Pseudomonas paraeruginosa 12924 WDCM 00026 9027 Raoultella planticola 9528 — — Saccharomyces cerevisiae 
3191 — 9763 Saccharomyces cerevisiae 
3275 — — Salmonella enterica 
6017 WDCM 00029 BAA-2162 Model Ficha Salmonella enterica 
6676 — — Ficha Salmonella enterica 
12023 WDCM 00031 14028 Model Ficha Serratia marcescens 10211 — 13880 Shigella flexneri 12698 WDCM 00126 12022 Staphylococcus aureus 
6571 WDCM 00035 9144 Ficha Staphylococcus aureus 
7447 WDCM 00033 / 00195 6538P Ficha Staphylococcus aureus 
10788 WDCM 00032 / 00193 6538 Ficha Staphylococcus aureus 
12493 WDCM 00212 — Model Ficha Staphylococcus aureus 
12973 WDCM 00131 29213 Model Ficha Staphylococcus aureus 
12981 WDCM 00034 25923 Model Ficha Staphylococcus aureus 
13373 WDCM 00211 43300 Model Ficha Staphylococcus aureus 
13552 — — Model Ficha Staphylococcus aureus 
13811 — BAA-977 Model Ficha Staphylococcus aureus 
13812 — BAA 976 Model Ficha Staphylococcus aureus 
13813 — BAA 1708 Model Ficha Staphylococcus aureus 
14033 — BAA 1026 Model Ficha Staphylococcus epidermidis 
11047 WDCM 00132 14990 Model Ficha Staphylococcus epidermidis 
13360 WDCM 00036 12228 Model Ficha Staphylococcus xylosus 11043 — 29971 Stenotrophomonas maltophilia 10257 — 13637 Streptococcus agalactiae 
8181 — 13813 Model Ficha Streptococcus equi 
7023 — 43079 Streptococcus mutans 
10449 — 25175 Streptococcus pneumoniae 
12977 — 49619 Model Ficha Streptococcus pyogenes 
12696 — — Model Ficha Tatlockia micdadei 11371 — 33218 Vibrio furnissii 
11218 WDCM 00186 — Vibrio parahaemolyticus 
10903 WDCM 00037 17802 Yersinia enterocolitica 11176 — —
Comply with the BrCAST recommendations
Comply with the CLSI recommendations
Nota 1: UKHSA licensed NCTC and CPF Strains are equivalent to the ATCC® strains referenced in this table.
Nota 2: Strains can be purchased separately or monthly with one, two or four units.
Nota 3: Strains not listed available on request.• Refractometry
Refractive Index (20ºC)
ºBrix (20ºC)- Reticulocytes
- CLProgramReticulocytes – AutomatedCategoryClinical, Hematology / Hematoscopy, Internal Control, Proficiency Testing
The EP is divided into 3 different programs according to the analytical systems served:
Reticulocytes – Automated: I – Alinity, Cell Dyn, Celltac, Mindray, Pentra, Urit and Yumizen systems.
Reticulocytes – Automated: II – Coulter Systems.
Reticulocytes – Automated: Sysmex – All Sysmex equipment.
- Reticulocytes – Automated
- IRF (Immature Reticulocyte Fraction)
- Ret-He (Reticulocyte Hemoglobin Content)
Reticulocytes – manual
- CLProgramRheumatoid Factor – ImmunologyCategoryClinical, Immunology / Proteins, Internal Control, Proficiency Testing
- Rheumatoid Factor
- Anti-filaggrin antibodies
- Anti-profilagrin antibodies
- CLProgramRheumatoid Factor – Immunology Cavitary FluidsCategoryBody Liquids, Clinical, Proficiency Testing, Releases
- Rheumatoid Factor.
- CLProgramRotavirus: AntigenCategoryClinical, Infectious Diseases, Internal Control, Proficiency Testing
Rotavirus: Antigen
- VETProgramRotavirus: Antigen TestCategoryInfectious Diseases, Internal Control, Proficiency Testing, Veterinary
Rotavirus: Antigen Test
- CLProgramRubella – ImmunologyCategoryClinical, Infectious Diseases, Internal Control, Proficiency Testing
- Rubella IgG
- Rubella IgM
- IgG Avidity
- 17-beta-estradiol
- 17OH Progesterone
- Alpha-amylase
- Androstenedione
- cortisol
- DHEA
- Estriol
- Estrone
- IgA
- Lysozyme
- Melatonin
- pH
- Progesterone
- SDHEA
- Testosterone
- CLProgramSalmonella – Molecular BiologyCategoryClinical, Genetics and Molecular Biology, Proficiency Testing
The program includes PCR-based molecular testing.
The samples contain the complete genome of the microorganism.Detection by Molecular Biology of:
- Salmonella enteritidis
- Salmonella sp
- Salmonella typhimurium
- VETProgramSalmonella – Molecular BiologyCategoryGenetics and Molecular Biology, Proficiency Testing, Veterinary
The program includes PCR-based molecular testing.
The samples contain the complete genome of the microorganism.- Salmonella enteritidis
- Salmonella gallinarum
- Salmonella pullorum
- Salmonella spp.
• Salt: Iodate
Determination of Iodine (Iodate)• Salt: Iodide
Determination of Iodine (Iodide)• Salt: Humidity
Humidity• Sanitizing agents: Bleach water
Active chlorine content
pH (25°C)
pH (25°C) at 1%Identification of Ectoparasite
Sea Water
Count of:
• Thermotolerant Coliforms (45ºC)
• Enterococcus sp.
• Escherichia coliErythrocytes
Erythrocytes Automation
Erythrocytes (Chamber)
Erythrocytes MicroscopyLeukocytes
Leukocytes Automation
Leukocytes (Chamber)
Leukocytes MicroscopySedimentoscopy Urinalysis (Identification)
- CLProgramSequencing: Detection of the Bacterial GenomeCategoryClinical, Genetics and Molecular Biology, Proficiency Testing
The program includes PCR-based molecular testing.
The samples contain the complete genome of the microorganism.- Identification of bacteria by sequencing
- CLProgramSequencing: Fungal and Yeast Genome DetectionCategoryClinical, Genetics and Molecular Biology, Proficiency Testing
The program includes PCR-based molecular testing.
The samples contain the complete genome of the microorganism.Identification of Fungi and Yeasts by Sequencing.
- CLProgramSequencing: Newborn ScreeningCategoryClinical, Genetics and Molecular Biology, Proficiency Testing
The program includes PCR-based molecular testing.
The samples contain the complete genome of the microorganism.- Pesquisa de anticorpos intravasculares – TAD (Coombs Direto)
- CLProgramSequencing: Viral Genome DetectionCategoryClinical, Genetics and Molecular Biology, Proficiency Testing
The program includes PCR-based molecular testing.
The samples contain the complete genome of the microorganism.-
Identification of viral pathogens by sequencing.
-
Serology Anti-HBc
Serology Anti-HBe
Serology Anti-HBs
Serology Anti-HCV
Serology Anti-HIV
Serology Anti-HTLV
Serology Chagas
Serology HBeAg
Serology HBsAg
Serology Sífilis
Serology V
- Anti-HDV
Related tests
- ¹Delta Hepatitis
- VETProgramSerum Amyloid A (SAA) – FelineCategoryPoint of Care Testing (PoCT), Proficiency Testing, Veterinary
- Serum Amyloid A (SAA) – Feline
Calprotectin
- CLProgramSpecific Proteins, Protein Electrophoresis and ImmunoproteinsCategoryClinical, Immunology / Proteins, Internal Control, Proficiency Testing
Protein Electrophoresis
- Albumin (Percentage)
- Albumin (Quantitative)
- Alpha I
- Alpha II
- Beta
- Beta I
- Beta II
- Gamma
- Pre-albumin
- Total Proteins (Quantitative)
Immunoproteins I
- Alpha1-Acid Glycoprotein
- AH-50
- Amyloid A
- C1q Complement
- C2 Complement
- C3 Complement
- C3 Proactivator Complement
- C4 Complement
- C5 Complement
- C8 Complement
- C9 Complement
- IgA (immunoglobulins A)
- IgD (immunoglobulin D)
- IgE (immunoglobulin E)
- IgG (immunoglobulin G)
- IgM (immunoglobulin M)
- C1 Esterase Inhibitor
(IgG) (1 to 4)
Immunoproteins II
- Total Complement (CH50/CH100)
Specific Proteins
- Alpha-1-antitrypsin
- Alpha-2-macroglobulin
- Kappa Free Light Chain
- Lambda Free Light Chain
- Ceruloplasmin
- Haptoglobin
- Hemopexin (Hpx)
- Kappa Light Chain
- Lambda Light Chain
- Retinol-Binding Protein
- Kappa Free / Lambda Free Ratio
- Kappa Free Light / Lambda Free Light Ratio
- CLProgramSpectrophotometryCategoryClinical, Clinical Chemistry, Internal Control, Proficiency Testing
Spectrophotometry
Absorbance readings available- 340 nm
- 400nm
- 405nm
- 420nm
- 450nm
- 460nm
- 475nm
- 500nm
- 505nm
- 510nm
- 520nm
- 530nm
- 546nm
- 550nm
- 560nm
- 578nm
- 580nm
- 590nm
- 600nm
- 620nm
- 635nm
- 670nm
- 700nm
• Only the indicated wavelengths can be tested.
- CLProgramSperm Cell Count and VitalityCategoryClinical, Internal Control, Proficiency Testing, Reproduction Medicine
- Sperm Concentration
- Post-Vasectomy Sperm Count
- Total Sperm (THO)
- live sperm
- Normal Sperm
- Peroxidase Positive Cell Count
- Relevant Defects
- Germinative Elements
- Red Cells
- Leukocytes
- Relevant Germinal Elements
- Red blood cells (panoptic)
- Relevant Leukocytes
- Total Peroxidase Positive Cells
Motility
- Sperm Motility Percentage
Progressive Motility
- Percentage of sperm with Progressive Motility
- Percentage of sperm with non-progressive motility
- Motionless
- CLProgramSporothrix schenckii – Molecular BiologyCategoryClinical, Genetics and Molecular Biology, Proficiency Testing
The program includes PCR-based molecular testing.
The samples contain the complete genome of the microorganism.- Detection of Sporothrix schenckii
- CLProgramStaphylococcus – Molecular BiologyCategoryClinical, Genetics and Molecular Biology, Proficiency Testing
The program includes PCR-based molecular testing.
The samples contain the complete genome of the microorganism.- Staphylococcus sp.
- Staphylococcus aureus
- Staphylococcus epidermidis
- Staphylococcus saprophyticus
- MICROProgramSterile Pharmaceutical ProductsCategoryMicrobiological, Microbiology, Pharmaceutical Field, Proficiency Testing
These programs include tests designed for routine analysis of sterile pharmaceutical products (injectable solutions, ophthalmic solutions, products for parenteral use, etc.)
Sterile Pharmaceutical Products I: Sterility Test
Sterile Pharmaceutical Products II: Endotoxin Determination
- Sugar: Polarization
Polarization
- Sugar: Polarization
- Chloride
- NaCl for Conductivity
- Sodium
- Sweat for Osmolality
Related tests
- Sweat test
- Symmetric Dimethylarginine (SDMA)
- Cristals
- Syphilis IgG
- Syphilis IgM
• Tablets: Acetylsalicylic Acid
Content
Dissolution
Identification• Tablets: Atenolol
Content
Dissolution
Identification• Tablets: Dipyrone
Content
Dissolution
Identification• Tablets: Physical Tests
Average weight
Disintegration
Toughness
Friability Quantitative
Friability Qualitative• Tablets: Hydrochlorothiazide
Content
Dissolution
Identification• Tablets: Mebendazole
Content
Dissolution
Identification• Tablets: Nimesulide
Content
Dissolution
Identification• Tablets: Paracetamol
Content
Dissolution
Identification- Amitriptyline
- Busulfan
- Ceftriaxone
- Chlorpromazine
- Citalopram
- Clomipramine
- Digitoxin
- Furosemide
- Levetiracetam
- Posaconazole
- Vigabatrin
- Voriconazole
- Oxcarbazepine
- 10-Hydroxy Carbamazepine
• Tests Limits I
Chloride
Sulfate• Tests Limits II
Ammonia
Iron- CLProgramTherapeutic Drugs ICategoryClinical, Internal Control, Proficiency Testing, Therapeutic Drugs Monitoring
- Acetaminophen
- Alprazolam
- Amikacin
- Amiodarone and
- Metabolite
- Bromazepam
- Caffeine
- Carbamazepine
- Clobazam
- Clonazepam
- Clozapine
- Diazepam
- Digoxin
- Ethosuximide
- Fluoxetine
- Flurazepam
- Gabapentin
- Gentamicin
- Haloperidol
- Lacosamide
- Lamotrigine
- Lidocaine
- Lorazepam
- Methotrexate
- Mitotane
- Nitrazepam
- Phenobarbital
- Phenytoin
- Primidone
- Quinidine
- Risperidone
- Salicylate
- Theophylline
- Tobramycin
- Topiramate
- Valproic acid
- Vancomycin
- Zonisamide
Program compatible with all methodologies used in thromboelastography testing.
Available assays:
-
Amplitude 10 (mm)
-
Alpha angle (°)
-
Maximum Clot Firmness (mm)
-
Maximum Lysis (%)
-
Clotting Time (s)
-
Clot Formation Time (s)
-
• Titration Acid/Base
Titration- HEMOProgramTLR Seleção de Doadores – HemoglobinaCategoryHematology / Hematoscopy, Hemotherapy, Immunohematology / Transfusion Medicine, Proficiency Testing
- Hemoglobina
¹Exames relacionados
Teste laboratorial remoto Hemoglobina
Teste rápido Hemoglobina
- CLProgramToxicology ICategoryClinical, Internal Control, Occupational Toxicology / Abuse Drugs, Proficiency Testing
Metals
- Aluminum
- Boron
- Copper
- Chrome
- Manganese
- Nickel
- Selenium
- Thallium
- Zinc
Not Metals
- Beta-2-microglobulin
- Bromide
- Cotinine
- Creatine
- Nicotine
- Serotonin
- CLProgramToxicology IICategoryClinical, Internal Control, Occupational Toxicology / Abuse Drugs, Proficiency Testing
Trace Elements
- 1,2 Dihydroxy-4-(N-acetylcysteinyl)butane
- 2-ethoxyacetic acid
- 2-thio-thiazolidine acid
- 4-chlorocatechol
- 5-aminolevulinic acid (5-ALA)
- Bromide
- Butoxyacetic Acid
- Cyclohexane
- Fluoride
- Formic acid
- Hippuric Acid
- Hydroxypyrene
- Mandelic Acid
- N-methylformamide
- P-aminophenol
- Pentachlorophenol
- Phenol
- Phenylglyoxylic acid
- S-phenyl mercapturic acid
- Tetrahydrofuran (THF)
- Thiocyanate
- Total Methyl Hippuric Acid
- Trans Muconic Acid
- Trichloroacetic acid
Metals
- Aluminum
- Antimony
- Arsenic
- Bismuth
- Cadmium
- Chrome
- Cobalt
- Copper
- Lead
- Lithium
- Magnesium
- Manganese
- Mercury
- Nickel
- Selenium
- Thallium
- Tin
- Vanadium
- Zinc
- CLProgramToxicology IIICategoryClinical, Internal Control, Occupational Toxicology / Abuse Drugs, Proficiency Testing
- Aluminum
- Antimony
- Arsenic
- Beryllium
- Bismuth
- Cadmium
- Chrome
- Cobalt
- Copper
- Lead
- Manganese
- Mercury
- Molybdenum
- Nickel
- Selenium
- Silver
- Thallium
- Tin
- Vanadium
- Zinc
Toxicology IV: Serum
- Acetone
- Benzene
- Ethanol
- Ethylene glycol
- Isopropanol
- Methanol
Toxicology V: Urine
- Acetaldehyde
- Acetone
- Ammonia
- Ethanol
- Formaldehyde
- Isopropanol
- Methanol
- Methyl ethyl ketone
- Methyl Isobutyl Ketone
- O-cresol
- Toluene
- Total Trichlorocompounds
Toxicology VI: Whole Blood
- Acetone
- Ammonia
- Ethanol
- Ethylene glycol
- Isopropanol
- Methanol
- 2.5 Hexanedione
- CLProgramToxicology VIIICategoryClinical, Internal Control, Occupational Toxicology / Abuse Drugs, Proficiency Testing
- Ammonia
- Carboxyhemoglobin
- Methemoglobin
- VETProgramToxoplasma gondii – Molecular BiologyCategoryGenetics and Molecular Biology, Proficiency Testing, Veterinary
The program includes PCR-based molecular testing.
The samples contain the complete genome of the microorganism.- Toxoplasma gondii
- CLProgramToxoplasma gondii – Molecular BiologyCategoryClinical, Genetics and Molecular Biology, Proficiency Testing
The program includes PCR-based molecular testing.
The samples contain the complete genome of the microorganism.- Detection of Toxoplasma gondiiby.
- CLProgramToxoplasmose – ImmunologyCategoryClinical, Infectious Diseases, Internal Control, Proficiency Testing
- Toxo IgG
- Toxo IgM
- Toxo IgA
- Total Toxo
- IgG Avidity
- CLProgramTRAB ImmunologyCategoryClinical, Immunoassays / Endocrinology, Internal Control, Proficiency Testing
- TRAB (Anti-TSH receptor antibody)
These programs includes tests for the routine analysis of drinking, mineral, purified, dialysis, injectable, bottled, ice, well and recreational (pool) water.
Treated Water I
Counting of:
• Heterotrophic BacteriaResearch of:
• Thermotolerant Coliform
• Total Coliform
• Escherichia coli
• Pseudomonas aeruginosaTreated Water II
Counting of:
• Total Coliform (35°C)
• Spores of Aerobic Bacteria
• Staphylococcus aureusResearch of:
• Enterococcus spp
• Sulphite Reducing ClostridiaTryptase
- CLProgramTumor MarkersCategoryClinical, Immunoassays / Endocrinology, Internal Control, Proficiency Testing
Tumor Markers I
- CA 125
- CA 15-3
- CA 19-9
- CA 27-29
- CA 50
Tumor Markers II
- Anti-thyroglobulin (Anti-Tg)
- Beta-2-microglobulin
- BTA (Bladder Tumor Antigen)
- CA 72-4
- CEA (Carcinoembryonic Antigen)
- Chromogranin A
- Chromogranin B
- Complex PSA
- CYFRA 21-1
- Free PSA
- HE4 antigen
- Pancreatic Polypeptide (PP)
- Pituitary Glycoprotein Hormones
- Polypeptide Tissue Antigen (TPA)
- S-100 protein
- Specific Neural Enolase (NSE)
- Squamous Cell Carcinoma (SCC) Antigen
- Total PSA
- Vasoactive Intestinal Peptide (VIP)
Tumor Markers III
- Alpha Fetoprotein (AFP)
- Beta-hCG
- Thyroglobulin (TG)
Tumor Markers IV
- Calcitonin (hCT)
- VETProgramUrinalysis – Abnormal Elements and BiochemistryCategoryInternal Control, Proficiency Testing, Urinelysis, Veterinary
Urinálise Elementos Anormais
- Bilirrubina Total
- Corpos Cetônicos
- Glicose
- Hemoglobina Hemolisada
- Leucócitos
- Nitrito
- Proteínas
- Urobilinogênio
- pH (tira)
- pH (automação)
- Densidade (automação)
Urinálise Bioquímica
- Cálcio Total
- Creatinina
- gGT
- Glicose
- Proteínas Totais
- Epithelial Cells
- Squamous Epithelial Cells
- Non-Squamous Epithelial Cells
- Crystals
- Red blood cells
- Leukocytes
-
Albumin
-
Albumin/Creatinine
-
Amylase
-
Chloride
-
Creatinine
-
Density by Automation (densitometer or refractometer)
-
Free Cortisol
-
Glucose
-
Magnesium
-
Osmolality
-
pH by automation
-
Phosphorus
-
Potassium
-
Sodium
-
Total Calcium
-
Total Protein
-
Urea
-
Urea Nitrogen
-
Uric Acid (Urate)
-
Urine Culture¹
- Identification
- Colony Count
- Culture
- Antimicrobial Susceptibility Testing – AST
¹Related Test
Uroculture
- CLProgramVaricella-Zoster – ImmunologyCategoryClinical, Infectious Diseases, Internal Control, Proficiency Testing
- Varicella-Zoster IgA
- Varicella-Zoster IgG
- Varicella-Zoster IgM
- CLProgramVaricella-Zoster – Molecular BiologyCategoryClinical, Genetics and Molecular Biology, Proficiency Testing
The program includes PCR-based molecular testing.
The samples contain the complete genome of the microorganism.- Detection of Varicella-Zoster.
- CLProgramVisceral LeishmaniasisCategoryClinical, Infectious Diseases, Internal Control, Proficiency Testing
- IgG Visceral Leishmaniasis
- IgM Visceral Leishmaniasis
- Total Visceral Leishmaniasis
- VETProgramVisceral Leishmaniasis – CanineCategoryInfectious Diseases, Proficiency Testing, Veterinary
- Leishmaniose Visceral Canina IgG
- Leishmaniose Visceral Canina Total
Vitamin C¹
Related test
¹Ascorbic acid
Water I (Drinking water, mineral and natural, purified, swimming pool and dialysis water)
Counting of:
• Heterotrophic Bacteria • Thermotolerant Coliform
• Total Coliform (35°C) • Escherichia coliResearch of:
• Thermotolerant Coliform • Total Coliform
• Escherichia coliWater II (Natural, purified and mineral water)
Counting and research of:
• Pseudomonas aeruginosaWater III (Mineral and natural water)
Research of:
• Sulphite Reducing Clostridia • Enterococcus spp.Water IV (Swimming pool water)
Counting of:
• Total Coliform (35°C) • Staphylococcus aureusWater Endotoxin
Determination of:
• Endotoxin (Semi-Quantitative and Quantitative)Water Fungus Count
• Fungi
Water Salmonella spp and Shigella spp
Counting of:
• Salmonella spp.Research of:
• Salmonella spp. • Shigella spp.Water VIII (Spores of Aerobic Bacteria)
Counting of:
• Spores of Aerobic BacteriaWater – Research of Giardia spp.
Research of:
• Giardia spp.Water – Research and Counting of Legionella spp.
Counting and research of:
• Legionella spp.Water I (Drinking water, mineral and natural, purified, swimming pool and dialysis water)
Counting of:
• Heterotrophic Bacteria • Thermotolerant Coliform
• Total Coliform (35°C) • Escherichia coliResearch of:
• Thermotolerant Coliform • Total Coliform
• Escherichia coliWater II (Natural, purified and mineral water)
Counting and research of:
• Pseudomonas aeruginosaWater III (Mineral and natural water)
Research of:
• Sulphite Reducing Clostridia • Enterococcus spp.Water IV (Swimming pool water)
Counting of:
• Total Coliform (35°C) • Staphylococcus aureusWater Endotoxin
Determination of:
• Endotoxin (Semi-Quantitative and Quantitative)Water Fungus Count
• Fungi
Water Salmonella spp and Shigella spp
Counting of:
• Salmonella spp.Research of:
• Salmonella spp. • Shigella spp.Water VIII (Spores of Aerobic Bacteria)
Counting of:
• Spores of Aerobic BacteriaWater – Research of Giardia spp.
Research of:
• Giardia spp.Water – Research and Counting of Legionella spp.
Counting and research of:
• Legionella spp.Water – Research of Giardia spp.
Research of:
• Giardia spp.Water – Research and Counting of Legionella spp.
Counting and research of:
• Legionella spp.Water – Salmonella spp and Shigella spp
Counting of:
• Salmonella spp.Research of:
• Salmonella spp.
• Shigella spp.• Water and Effluent – Alkalinity
Alkalinity• Water and Effluent – Bicarbonate
Bicarbonate• Water and Effluent – Carbonate
Carbonate• Water and Effluent – Free Residual Chlorine
Free Residual Chlorine• Water and Effluent – Free CO2
Free CO2• Water and Effluent – Hardness
Hardness• Water and Effluent – Silica
Silica- PCProgramWater and Effluent – DemandsCategoryPhysicochemical, Proficiency Testing, Water & Environment
• Water and Effluent – BOD
Biochemical Oxygen Demand (BOD)• Water and Effluent – COD
Chemical Oxygen Demand (COD) - PCProgramWater and Effluent – Dissolved OxygenCategoryPhysicochemical, Proficiency Testing, Water & Environment
• Water and Effluent – Dissolved Oxygen
Dissolved Oxygen • Water and Effluent: Free Cyanide
Free Cyanide• Water and Effluent: Chloride
Chloride• Water and Effluent: Fluoride
Fluoride• Water and Effluent: Orthophosphate
Orthophosphate• Water and Effluent: Sulfate
Sulfate• Water and Effluent: Sulfide
Sulfide• Water and Effluent: Sulphite
Sulphite- PCProgramWater and Effluent – MetalsCategoryPhysicochemical, Proficiency Testing, Water & Environment
• Water and Effluent – Aluminum
Aluminum• Water and Effluent – Antimony and Thallium
Antimony
Thallium• Water and Effluent – Arsenic
Arsenic• Water and Effluent – Barium
Barium• Water and Effluent – Boron
Boron• Water and Effluent – Cadmium
Cadmium• Water and Effluent – Calcium
Calcium• Water and Effluent – Cobalt
Cobalt• Water and Effluent – Copper
Copper• Water and Effluent – Hexavalent Chromium
Hexavalent Chromium• Water and Effluent – Iron
Iron• Water and Effluent – Lead
Lead• Water and Effluent – Lithium
Lithium• Water and Effluent – Magnesium
Magnesium• Water and Effluent – Manganese
Manganese• Water and Effluent – Mercury
Mercury• Water and Effluent – Nickel
Nickel• Water and Effluent – Potassium
Potassium• Water and Effluent – Selenium
Selenium• Water and Effluent – Silver
Silver• Water and Effluent – Sodium
Sodium• Water and Effluent – Strontium
Strontium• Water and Effluent – Tin
Tin• Water and Effluent – Total Chromium
Total Chromium• Water and Effluent – Vanadium
Vanadium• Water and Effluent – Zinc
Zinc - PCProgramWater and Effluent – NitrogenatesCategoryPhysicochemical, Proficiency Testing, Water & Environment
•Water and Effluent: Ammoniacal Nitrogen
Total Ammoniacal Nitrogen• Water and Effluent: Nitrogen (Nitrate)
Nitrogen (Nitrate)• Water and Effluent: Nitrogen (Nitrite)
Nitrogen (Nitrite) - PCProgramWater and Effluent – OrganicCategoryPhysicochemical, Proficiency Testing, Water & Environment
Water and Effluent – Total Phenols
Total Phenols• Water and Effluent – Oils and Greases
Oils and GreasesWater and Effluent – Surfactant
Surfactant• Water and Effluent – Toluene
Toluene - PCProgramWater and Effluent – SalinityCategoryPhysicochemical, Proficiency Testing, Water & Environment
• Water and Effluent – Salinity
Salinity - PCProgramWater and Effluent – SolidsCategoryPhysicochemical, Proficiency Testing, Water & Environment
• Water and Effluent – Total Dissolved Solids
Total Dissolved Solids• Water and Effluent – Sedimentable Solids
Sedimentable Solids• Water and Effluent – Total Suspended Solids
Total Suspended Solids• Water and Effluent – Total and Fixed Solids
Total and Fixed Solids - PCProgramWater and Effluent: Apparent ColorCategoryPhysicochemical, Proficiency Testing, Water & Environment
• Water and Effluent: Apparent Color
Apparent Color - PCProgramWater and Effluent: TurbidityCategoryPhysicochemical, Proficiency Testing, Water & Environment
• Water and Effluent: Turbidity
Turbidity Water Endotoxins
Determination of:
• Endotoxin (Semi-Quantitative and Quantitative)Water for Injections
Count of:
• Heterotrophic Bacteria
• Total Mesophilic MicroorganismsDetermination of:
• Endotoxin (Semi-Quantitative)
• Wheat Flour: Total Fat
Total Fat• Wheat Flour: Granulometry
Granulometry• Wheat Flour: Moisture
MoistureWidal Reaction¹
Related Test
¹Gruber-Widal Test
- Yellow Fever IgG
- Yellow Fever IgM
- CLProgramYellow Fever – Molecular BiologyCategoryClinical, Genetics and Molecular Biology, Proficiency Testing
The program includes PCR-based molecular testing.
The samples contain the complete genome of the microorganism.- Detection of Yellow Fever.
- CLProgramZika Virus – ImmunologyCategoryClinical, Infectious Diseases, Internal Control, Proficiency Testing
- Zika Virus IgG
- Zika Virus IgM
- CLProgramZika Virus – Molecular BiologyCategoryClinical, Genetics and Molecular Biology, Internal Control, Proficiency Testing
The program includes PCR-based molecular testing.
The samples contain the complete genome of the microorganism.- Detection of Zika Virus.